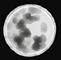

GUÍAS ETNOBIOLÓGICAS DE COLOMBIA

ISSN: 2711-306X ISSN EN LÍNEA: 2745-1534 J ÍI BEGEJ I M I NA’A ‘GENTE DE OTROS TIEMPOS’:


Apoyan Facultad de Ciencias Programa Gestión de Proyectos División de Acompañamiento Integral Dirección de Bienestar Sede Bogotá Relatos de animales y plantas del pueblo Féenem na’a - Muinane, del Medio Caquetá



– guías etnobiológicas de colombia –j íi begej i m i na’a ‘Gente de otros tiempos’: relatos de animales y plantas del pueblo féenem i na’a - muinane, del medio caquetá ISSN: 2711-306X // ISSN en línea: 2745-1534 número 3
Universidad Nacional de Colombia Facultad de Ciencias
Sede Bogotá
GUÍAS ETNOBIOLÓGICAS DE COLOMBIA, Guías etnobiológicas de Colombia es una publicación periódica en alianza con el grupo estudiantil “MUI” de la Facultad de Ciencias de la Universidad Nacional de Colombia en la que se resalta la importancia del conocimiento cultural, biológico y lingüístico de los pueblos indígenas en diálogo con la academia.
En esta tercera edición profundizamos en las historias y consejos que rememoran un tiempo en el que el mundo era habitado por otra humanidad. Estas expresiones del pueblo féenemina’a sobre esta anterior humanidad (que devendrá en animalidad) asoman otra posibilidad de percibir a nuestros interlocutores no-humanos: reconociendo la capacidad de intención inherente en ellos y formulando desde ahí otra ecología posible.

contacto del grupo grupoestudiantilmui@gmail.com /instagram.com/guiasetnobiologicascol
proyectoug_bog@unal.edu.co 3165000 ext: 10661-10662
/gestiondeproyectosUN @pgp_un issuu.com/gestiondeproyectos
Las ideas y opiniones presentadas en los textos de la siguiente publicación son responsabilidad exclusiva de sus respectivos autores y no reflejan necesariamente la opinión de la Universidad Nacional de Colombia.
rectora / Dolly Montoya Castaño vicerrector de sede / José Ismael Peña Reyes director bienestar sede bogotá / Oscar Oliveros jefe de acompañamiento integral
/ Zulma Edith Camargo Cantor coordinador programa de gestión de proyectos pgp / William Gutierréz Moreno decano facultad ciencias / Giovanni Garavito Cardenas director bienestar facultad ciencias / María Argenis Bonilla Gómez
comité editorial
dirección
/ María Consuelo de Vengoechea Rodríguez
Coordinación
/ Andrés David Jiménez Maldonado / Christian Andrés Cárdenas Carrillo / David Ramírez Almanza / Tomás Hernando Rojas Tafur
edición
Todas y todos los autores participaron en la edición del volumen
autores y autoras
/ Eduardo Paky - Sabedor Féenemi na’a, clan gente de Coco de cumare / Libardo Mukutuy - Sabedor Féenemi na’a, clan gente de Gusano / Marcelino Fiagama Suárez - Sabedor Ni pode, clan Caimo - Sabedor Féenemi na’a, clan Churuco / Diego Alexander Aguilera Velasco - Estudiante de licenciatura en
/ Heine Rafael Gutiérrez Delgado/ Ruben Eduardo Mora Moreno -
ilustrado por

/ Fillippe Paky / Euclides Ortiz / Camila S. Venega
/ Christian A. Cardenas, Diego A. Aguilera / Esteban Ortíz
/ Nicol / Sergio Mukutuy / David Roman / Juan Sebastian Boaga
/ Juan Pablo Mukutuy / Ezequiel Mukutuy / Wiston Suárez López
/ Francisco Javier Suárez / Aurelio Suárez / Libardo Mukutuy
/ Saulo Mukutuy / Yinelkin Paky
/ Tomas Tafur / Christian Mukutuy
materal fotográfico
Camila Sofia Venegas Osorio / Christian Andrés Cárdenas Carrillo / Diego Alexander Aguilera Velasco
/ Heine Rafael Gutierrez Delgado / Nicolas Ernesto Valdivieso Beltran / Tomas Hernando Rojas Tafur
mapa
/ Andrés David Jiménez Maldonado
convenciones
imagen de portada y contraportada Dibujo principal: “Baile de charapa” de Fillippe Paky, de Villazul. Editado por Diego Aguilera.
corrección de estilo / Manuela Rondón Triana (PGP)
diseño y diagramación / Alejandro Sepúlveda @alga.voraz (Simbionte ediciones)
universidad nacional de colombia Sede Bogotá Edificio Uriel Gutiérrez Sede Bogotá www.unal.edu.co

M NA’A
DE OTROS
J BEGEJ
‘GENTE
TIEMPOS’: Relatos de animales y plantas del pueblo Féenem na’a - Muinane, del Medio Caquetá GUÍAS ETNOBIOLÓGICAS DE COLOMBIA
AGRADECIMIENTOS CONVENCIONES FICHA EXPLICATIVA INTRODUCCIÓN RELATO DE CREACIÓN DEL MUNDO
ARTRÓPODOS

Chi’éku 36 T íi fomogai 37 N íi bajejube’u 38 Méekiri 39 Dumójo nejékuga / Nejékume’i 40 Gachédi’u / Gisíre 42
34
íikuje 44 J íi ma’u 46 R í y i ’u / Ráyá’íigai 48 P íi n i / Pun ii 49
ANFIBIOS 50
Jakúkuga 52 Namíta’ i 54 Yítikirije 56 ‘éerije 58
Nijága 59 B í ri 60 Memé’uje 63
REPTILES 66
Juchá’i 68 Máv i 70 Búu’a 72 Yíruje 74
Igáiba i 75 Gíisibat i réje 76 Júpuku 78
12 14 17 18
22
AVES 80
Táakagañ i gai 82 Táa’ i 84 Déene 86 Jéek i / Jéek i Buya’u 88 Jách i me / Ját i me’u 90 Sí’uram i / Sí’uraje 92
Jítagachiku 94 Fáibe 96 Túumíba 98 Túumo’o 102 Bí’eje 104 ‘añ í m i med i 105
MAMÍFEROS 108
Kíiyiga / Fát i míj i ku 110 J i mú’ai 112 Jíiba’i 116 Táak i 117 Ji ku / Jebámi’unubajiku / Unuba’iko / Ménimiritidakaje / Nifáijiku 118
Nóobat i fai’u/ Néefim i t i fai’u 119 Jámana 120 Jéej i 122 T íi ’e 126 Fáafaiba 128
PLANTAS 130
Túugiy i 132 M i séseva 133 Ním i ’o 134 Mómo’o 135 Jáku’o 136 Báaku’o 137 T í si’o 138 N í kuje’e 139 ‘añaje’e 140 Kúme’e 141
Chére 142 ‘inó’o 143 Kuyá’o 144 Méjegi’o 145 M í s í ’o 146 Máni’o 147 Dé’e Usuta Decu i 148 Báño’o 149 Ján i gai 150
GLOSARIO ESPAÑOL REGIONAL 152 BIBLIOGRAFÍA 156
AGRADECIMIENTOS
El día que entregamos a las comunidades el primer número de las Guías Etnobiológicas de Colombia, un sabedor n pode se acercó a nosotros y nos dijo que por fin podría mos trarle a su nieta los animales del monte para que ella pudiera dibujarlos. Esta nueva versión de la guía trabajada con el pue blo féenem na’a conserva ese mismo espíritu. Por ello, que remos agradecer a todas las personas de las comunidades de Villa Azul y de Chukik que hicieron posible esta investiga ción, que da cuenta de una diversidad de especies de plantas y animales de la región y de sus diversas expresiones propias, pertenecientes a la diversidad cultural de este país.

En Villa Azul, agradecemos a Eduardo Paky, Adriano Paky, Avelino Paky, Hilda Cubeo, Angie Pijachi, Mario Paky, Ana Rita Andoque, Aidé Barbosa, Fillipe Paky, Rosmery Matapí, Claudia Paky, Jimmy Paky, Lenyi Andoque Miraña, Jorge Simeon Matapy Roticroke, Euclides Paky Barbosa, Edwin Pakky, Elio Paky e Idalí Barbosa.
En Chukik , agradecemos a Libardo Mukutuy, Saulo Mukutuy, Sergio Mukutuy, Ezequiel Mukutuy, Fátima Valencia, Rafael Mukutuy, Francisco Javier Suárez, Obdulia, Dolores Rodríguez, Blanca, Euclides Ortiz, Estela Perdomo, Jesús Ortiz, Esteban Ortiz, Lia Guiriña, Jorge Ortiz, Leopoldina Kudu, Willington Ortiz, Betriz, Eliceo Ortiz y María Kuyoteca.
12
En Araracuara, agradecemos a Rufina Román, Marcelino Fiagama, Berta, Nelly Andoque Buinaiconoma, Jhon Fredy Palacio Fenake, Luz Mery Huitoto, Irlando Palacio Andoque, y Aurelio Suárez.
A todos les damos las gracias por estar dispuestos a recibirnos un par de días en sus casas, brindarnos su alimento y por estar siempre abiertos a hablar con nosotros. Esta guía es apenas un abrebocas a todo el conocimiento que guardan las comu nidades indígenas sobre la biodiversidad con la que interac túan cotidianamente.
Agradecemos, además, el apoyo brindado por los proyectos: “Fortalecimiento del conocimiento y cuidado de la Selva y la Chagra desde la cultura y lengua de pobladores del medio Amazonas colombiano”, dirigido por la profesora Nubia E. Matta y financiado con la Convocatoria nacional para el fomento de alianzas interdisciplinarias en la Universidad Nacional de Colombia 2019-2021; así como a “La chagra, modelo experimental-pedagógico de agricultura sostenible, fuente de conocimiento ancestral, biodiversidad y puente de encuentro entre la academia y las comunidades indígenas”, dirigido por la profesora Johana Soto del departamento de biología y financiado con la convocatoria de extensión soli daria 2020. Estos permitieron financiar la estadía en campo de los miembros del equipo de investigación.
A Bienestar de Facultad de Ciencias y al Programa de Gestión de Proyectos del Área de Acompañamiento Integral de Bienestar sede Bogotá les damos las gracias por financiar la publicación de esta guía.
13
HÁBITO










CONVENCIONES
INCLUIDA EN ALGÚN APÉNDICE CITES 1

1. Corresponde a listas de especies de animales y plantas que tienen diferentes niveles y tipos de protección ante la explotación excesiva. Apéndice I: especies con mayor grado de peligro de extinción; por ello, la CITES prohíbe su comercio internacional y solo se per mite la importación no comercial (p. ej. investigación científica). Apéndice II: especies que no necesariamente están amenazadas de extinción, pero que podrían llegar a estarlo si no se controla estrictamente su comercio; así como las llamadas “especies semejantes” (especies cuyos especímenes objeto de comercio son semejantes a los de las especies incluidas por motivos de conservación). Su comercio puede autorizarse concediendo un permiso de exportación o un certificado de reexportación. Apéndice III: especies inclui das a solicitud de una parte que ya reglamenta el comercio de dicha especie y necesita la cooperación de otros países para evitar la explotación insostenible o ilegal de las mismas.


14
Hojarasca de árboles Acuático
Áreas
Fosorial Entre troncos Apéndice II Diurno Volador Apéndice I Arborícola
abiertas Apéndice III Nocturno
DIETA
CATEGORÍA DE AMENAZA SEGÚN LA UICN



Néctar
Frutos
Semillas

Coprófago
Artrópodos

Ramas Omnívoro




Mamíferos pequeños






Pasto Mamíferos medianos o grandes



Anfibios o reptiles Apéndice II Apéndice I Apéndice III

Carroñero
Hojas Peces
Vulnerable
Preocupación menor Datos insuficientes En peligro Casi amenazada
15
CONVENCIONES
PRESIONES Caza Minería Deforestación Quemas








VENENO EN GRADO DE PELIGRO

16
FICHA EXPLICATIVA
NOMBRE EN FÉENEM NA’A (muinane)
NOMBRE COMÚN O LOCAL EN ESPAÑOL
Identificación taxonómica (Autor, año)

Familia


♂ y ♀ 60-80 cm
Distribución: Se refiere a la distribución geográfica de la especie en cuestión.
Convenciones: Señalan los hábitos de vida del animal referenciado, además de especificar su dieta, estado de conserva ción y explotación, usos y presiones a las poblaciones naturales.



Información biológica: Incluye la descripción física del individuo, enfatizando en sus caracte rísticas más representativas y, según el caso, infor mación reproductiva.
Información etnobiológica: Incluye apartes de la información etnobiológica disponible según rela tos de miembros de la misma comunidad referente a cuentos, historias, narraciones, cantos, etc.

17
Crédito del autor: Fotografía de Sofía Venegas
INTRODUCCIÓN
El presente volumen de las Guías Etnobiológicas de Colombia presenta una serie de relatos del pueblo féenem na’a sobre algunos animales que habitan la región del Medio Caquetá. En el título, J begej m na’a, encontramos un aspecto fundamental de la manera de concebir y explicar la existencia de las especies de animales y plantas dentro del pensamiento de los féenem na’a: estos seres también son gente. Ellos forman parte de la primera humanidad creada por féenefiivobaño’otadi, el “abuelo tabaco de vida de centro”, para que habitara el mundo; fueron ellos quie nes asistieron al primer baile, habitaron las primeras malocas y consumieron sus primeras sustancias. Sin embargo, esta situa ción habría de cambiar, ya que, por distintos comportamientos de “desorden” desplegados por los animales, cada uno fue per diendo parte de su humanidad, y todos terminaron en el estado en el que se encuentran hoy en día.
Algunas de las historias se enfocan en las causas y consecuen cias de su especiación, y explican qué tuvo que haber pasado para que cierto animal llegara a portar un rasgo característico o comenzara a desplegar un comportamiento determinado. Esto da pie a que las narraciones también se conviertan en consejos que previenen a la humanidad actual, mostrándole las cosas buenas y las cosas malas llevadas a cabo por quienes nos pre cedieron. Es así como los relatos perviven en la memoria oral del pueblo como una serie de consejos, o fagóji, con los que abuelos, abuelas, padres y madres avisan a hijos, hijas, nietos y nietas sobre cuál debería ser su comportamiento para que, como ellos suelen decir: “no le pase como le pasó a tal animal”.

18
Esta guía ha nacido a partir del interés común entre inves tigadores, académicos e indígenas por realizar un ejercicio de comprensión y divulgación, uno que acerque a los lec tores al conocimiento etnobiológico construido en torno a la vida de los animales y las plantas que se encuentran en la región del Medio Caquetá. Este interés colectivo nos ha llevado a aproximarnos a estas especies desde una perspec tiva biológica, compartida en los centros de enseñanza aca démica, y una perspectiva etnobiológica, enseñada tanto en los espacios de vida de las comunidades como en el bosque, los ríos y la chagra.
La metodología para su elaboración consistió en establecer un lugar de trabajo en el que, en conjunto con las y los sabe dores de la comunidad, se revisaba especie por especie, con versando detenidamente acerca de cada una. Nos interesaba conocer su nombre en la lengua de la comunidad, si tenía alguna historia, consejo o canto, y si se conocía una manera especial de establecer sus relaciones entre esta y otras espe cies. Adicionalmente, con intención de complementar este trabajo, se invitó a niñas, niños y juventudes de los distin tos clanes a participar en jornadas de ilustración de can tos, narraciones y saber etnobiológico, en las que se todos se permitían a sí mismos plasmar cómo imaginaban dichos conocimientos transmitidos en la oralidad, cómo creían que eran visualmente.
A continuación, presentamos algunos de los relatos que fue ron recogidos en las comunidades de Chukik y Villa Azul, ubicadas en el resguardo Predio Putumayo y en el resguardo Nonuya de Villa Azul, respectivamente, como lo indica el Mapa 1. Algunos relatos se acompañan de las ilustraciones. De igual forma, se añade información biológica de las especies tales como su distribución geográfica, estado de conservación, hábi tos, dieta, etc. Sobre los relatos aquí presentes, vale la pena resaltar que su transcripción procura conservar en la mayor medida posi ble el discurso de las personas que los narraron, con el fin
19
de que, a la hora de que el lector se acerque a los relatos, los evoque de forma similar a como fueron narrados origi nalmente. Dicho interés reside en el hecho de hacer más evidente la importancia del conocimiento transmitido oral mente y la forma particular en que este proceso sucede en las comunidades: el español regional que se utiliza, las prác ticas lingüísticas heterogéneas que lo atraviesan y que defi nen una forma particular de expresarse y de relacionarse con los otros a través de la lengua.
Grafía de las palabras en la lengua féenemina’a
La lengua féenem na’a (muinane) (ISO 639-3 bmr) perte nece a la familia lingüística bora y algunas de sus característi cas más relevantes, según el sistema fonológico descrito por Vengoechea (2012), son:



20
Mapa 1. Mapa geográfico de la región del Medio Caquetá, en el que se observa la distribución de clanes, resguardos y PNN de la región. Elaborado por Andrés Jiménez en QGIS.
▶
Tiene catorce consonantes y seis vocales.
▶
Presenta una estructura silábica consonante/vocal [CV(:)].
Tiene dos tonos fonológicos: alto y bajo. Cuando la sílaba presenta alargamiento de la vocal puede tener tono alto/bajo. Si lo primero, la escribimos en ortografía como áa y corres ponde en fonología a una vocal pesada: [ɑ̂:]; si lo segundo, (áá) y en fonología: [ɑ́:].
▶
A nivel de la prosodia, la lengua presenta fenómenos como la glotalidad suprasegmental y armonía palatal que afecta a los morfemas.
A continuación, presentamos los símbolos que empleamos en la escritura ortográfica y su correspondencia en el sistema fonológico para la apropiada pronunciación de las palabras en lengua féenem na’a (muinane).
vocales
Fonología i u e o
Ortografía i u e o a
consonantes
Fonología p b ɸ β m t d s m ᶑ k g ʔ h
Ortografía p b f v m t d s m r k g ‘ j
En morfemas palatales las vocales y consonantes se escriben de la siguiente manera:
Fonos dentro de morfemas palatales ʲɑ ʲt ʲd ʲn o
Ortografía ai ch y ñ o a
21
Bilabial Alveolar Retrofleja Velar Glotal
RELATO DE CREACIÓN DEL MUNDO
En la cosmología de los muinane existen dos palabras con las que se asienta la humanidad: el “bien” y el “mal”. Primero fue el mal. Desde el principio de la creación del mundo de la oscuridad, eso [el mal] es lo que llamamos “palabra de tabaco de animal”, ‘áasim baño’o’ij . Eso existió primero, mucho antes de la creación del hombre. Después viene la palabra “vida”, el bien que llegó con el padre crea dor, mofíivobaño’otadi, “nuestro abuelo de tabaco de vida”. Estas dos palabras, el “bien” y “mal”, reinan el mundo. Esas dos palabras dividen la tierra, el agua, el aire, el sol, las ban cas. Cada una tiene lo que le pertenece. Tierra mala para el mal, tierra buena para el bien; agua mala para el mal, agua buena para el bien; aire malo para el mal, aire puro para el bien; el sol caliente para el mal; el sol de mediodía es para el bien, el que da la vida. Y así mismo la noche, la noche está dividida: desde la una de la tarde hasta las doce de la noche es para el mal, desde la una de la mañana hasta las doce del mediodía es para el bien. Por eso es que el humano desde la madrugada trabajaba hasta antes de las doce y de ahí para allá no hace trabajos, porque ya está funcionando el mal. Y en la noche, ya en el mambeadero, hay que estar aconsejan do[le al mal] que no moleste a la vida humana, [que] si va a andar, que ande a su manera, pero que no perjudique la vida humana. Después de que uno habla con él [el abuelo de tabaco], ahí sí uno descansa para uno amanecer y recibir la madrugada que ya es la vida del humano.

22
También existen bancas del bien y del mal. Las primeras son de aroma o dulzura y son donde el hombre debe sentarse, kúruba’ikaga , “asiento amarillo de azafrán”, o kúudi’ikaga , “asiento de pintura”, jáchume’ikaga , “asiento de pájaro azul”. Ya los pajaritos esos, que hablan y hablan bien, los pajari tos son los que amanecieron el día con alegría, náamo’ikaga , “asiento de dulzura”. ¿Cuál es la dulzura? La sal tostada. De ahí ya se prepara el ambil y con eso hay que hablar unas palabras buenas. Entonces esas son las palabras del bien, esas son las que uno tiene que usar para que no haya chis mes, problemas. Hay que rechazar los asientos malos y hay que recibir los asientos buenos. Los asientos malos son los de los animales de ‘ájeba’ikaga , “asiento de gusano rasqui ñoso”, p n ’ikaga , “asiento de araña grande (que vive en un hueco)”, j sim ’ikaga , “asiento de caracol” (con ese [se] habla mucho y es muy chismoso, pero [la conversación] no tiene progreso, se habla y se habla sin resultado). En el asiento de los micos uno vive recostándose, no está en lo que debe hacer. Así van los asientos. Cada cual tiene su función. Si uno vive rabioso, mentiroso, ladrón, está en el asiento del animal. Si uno está bien, está en el asiento bueno porque habla de cosas buenas, aconsejando y solo trabajando para la necesidad de esta vida.
Entonces, los insectos también tienen un origen. Entonces, [provienen] del asiento malo fue que formó níkun ba , “sol [astro] de pegante, sol pegajoso”. Él vivía sacando pepa de juansoco (Couma macrocarpa, Apocynaceae) y sacando el pegante. Con ese pegante él cogía a los pajaritos y los comía. Él oía a los pájaros y él comía. Él tenía una hija y ella mantenía en su vulva todas las crías de él, que eran los insectos, todo lo que pica: araña, alacranes, ciempiés, congas. Él los alimentaba con las tripas amargas de esos pájaros que él comía para que

23
tuvieran veneno. Así, cuando su hija tuviera una relación con un hombre, esos animales lo mordían, el hombre se moría y él los comía. Era como una trampa.
Un día llegó un hombre como vivo que se fue a vivir con ella, un joven llamado Séséeve , “lucero de la mañana”. Él se fue donde el papá de ella y le dijo que quería vivir con ella.
—Bueno—le contestó el papá— así han llegado muchos hombres y me dicen así y yo les digo “ahí está mi hija”, y después no resis ten y la abandonan y después dicen que yo soy malo. Bueno, ahí está ella. Si usted quiere, ahí está, vaya búsquela. Vaya duerma con ella —así le decía a todos los hombres.
Entonces un día Séséeve decidió acercarse a ella, cogió su bolsa de coca y se quedó sentado, y ahí vivían. Él se hacía el que dor mía y después se levantaba como para ir a cazar, pero no, él se regresaba. Así estuvo varios días. No se acostaba con ella. Un día él estaba en el mambeadero y la muchacha estaba acostada. Ella antes de dormirse atizó el fogón y se quedó dormida al lado en la hamaca con las piernas abiertas y Séséeve volteó a mirar donde ella y vio esa gusanera. Entonces él no tuvo relación con ella. Él le dijo al otro día al suegro:
—Suegro, nosotros con su hija vamos a ir a conseguir pescado en el río de danta. Allá vamos a ir a buscar cacería (a lo que hoy se conoce como Ciudad Perdida), vamos a moquear pescado y des pués venimos y hacemos trabajo.
—Bueno —dijo el suegro.
Entonces ellos se alistaron y le dijo a la mujer que llevara una yuca de comer asada, cocinada. Llegaron allá y él hizo un ran chito y se fue a una bocanita. Ahí él hizo un andamio, puso la trampa y cogió unos pescados. Llegó de tarde y le dijo a la mujer:
—Ase esa yuca bien y cocine los pescados y coma con eso.
—Bueno —dijo ella y comieron.

24
De noche él se fue otra vez a revisar a ver si cayeron más ani males en las trampas y se fue.
Él sacó harta leña para que, si caían pescados, él pudiera moquear. Cargó la leña. Cuando él regresó, ella se quedó dor mida al lado de la pasera y cuando él miró, [vio] la vulva de ella, [que estaba] con las piernas abiertas y con gusanera… Él empezó a cargar la leña y a hacer una hoguera de candela, luego cogió una raíz y comenzó a hurgar la vulva de ella. Ella quedó muy profunda, dormida. Comenzó a sacar los animales y los quemaba. Con una fibra de cumare (Astrocaryum aculea tum), lo envolvió [el cumare] en un palo y con esa fibra enre daba él a los animales y luego los quemaba; culebras, insectos, caracoles, arañas, alacranes, ciempiés, congas, todos los que son insectos los sacaba y los quemaba. Y apagaron [los insec tos] la candela porque eran demasiados. Lo que él no pudo acabar, ese resto de animales se regaron. Esos son los que ya quedaron en la tierra como insectos. Así se originaron todos los insectos, esos fueron los hijos de un tal sol de pegante.
Las aves, el padre creador las creó: perdices, gallineta, tente, pava, pava colorada, pava negra… Todas las aves grandes fueron formadas por el creador. Las aves pequeñas son los nietos del abuelo de enfriaje, son la alegría y la armonía del amanecer, pues madrugan a bañarse. Ellas hablaban, se reían al amanecer recibiendo el nuevo día. Hay entonces pájaros grandes, los que están más arriba en las copas de los árbo les, que no traen ningún mal; son como una autoridad y muestran cómo uno debe ser: joven, atractivo, amable, res petuoso, inteligente, alegre, como ellos (por eso en ciertas canciones que se cantan a los hombres se nombran estos pájaros para felicitar el comportamiento de las personas). [Existen también] los pájaros pequeños, los que son cucara cheros, los que van detrás de hormigas y que van cazando detrás de los demás, son pájaros de candelilla, los que siguen a las lombrices y los insectos. Por último, hay pajaritos que vienen con enfermedades y epidemias, traen plagas de tije retas, de cucarachas, etc.

25
En el momento de la creación se crean muchos animales: los peces, los pájaros, los árboles, etc. fueron la primera vida. Después los primeros animales fueron la primera gente. Por eso en algunas tribus, los clanes toman nombres de pájaros o de animales porque son [su] origen. Pero por los malos com portamientos, por el incumplimiento de las reglas que esta bleció el creador, él iba sancionando de una vez a la gente y los convertía en parte de la naturaleza. Así ha pasado varias veces (ahora ya estamos para que nos cambie otra vez porque ya estamos haciendo mucho desorden, abusando y estamos cerca a eso, por no cumplir las reglas). Entonces cuando el crea dor cambiaba a una generación, convertía a todos en animales. Pero, en la primera generación, los animales que [se] formaron se salvaron del diluvio en el “cerro del llanto”, como dicen los andoques. En la Biblia dice que [es el diluvio d]el arca de Noé, pero es el mismo. Después, cuando el diluvio mermó, el agua de candela que quemó el creador quedó en pozos que son el petróleo de hoy en día. Sobre todo eso, la tierra fue tapando: cada vez que el río (el agua bajo la tierra) subía, quedaba una capa tapando y así se tapó y seco la tierra. Después esa tierra se partió y se formaron los continentes y se separaron. Y noso tros quedamos como gente de centro, acá en “América del sur”, como le dicen.
Entonces los animales que se salvaron pasaron a la segunda generación y, para que ellos recibieran conocimiento, aparece el abuelo Machútabu’a, “boa de abundancia”. Él no fue creado por el creador, fue originado de la tierra como dios de esa gene ración; él apareció. Él formó el tabaco y la coca y eso tuvo con secuencias. Ahí aparecen las abuelas de esa generación, que se formaron de los insectos: el abejorro, la mariposa fueron las abuelas que él nombró; el grillo síisi, pun ’ , la araña peluda, hasta las ranas venenosas eran abuelas. Luego de la pepa de manicuera (yuca de tomar) nació una niña creada por el abuelo Machútabu’a. Para cuidarla, a ella la entregaban a las abuelas, pero a ella le daba rasquiña, le salía sarpullido y vivía llorando por todos los insectos, porque todo eso eran las abuelas y nin guna la pudo criar.

26
Silueta de un hombre frente a la quema de yarumo. Fotografía de Christian Cárdenas.

N n m tibatáago, “abuela de palma de sal de monte”, una que sacamos para sal que vive en la orilla como con hojas largui tas, ella fue [la abuela] que sí la recibió y la tranquilizó, por que ella es fría y ella sí la crio. Y ya con ella, él [Machútabu’a] le dijo a sus dos nietos para que se criaran como hermanos con ella [la niña], como hermana que él dio a ellos, y que con el producto de ella, ellos tenían que vivir, sin pensar en cacería ni nada, solo con lo que cultivaban. Si querían hacerlo tenían que avisarle a él, pero ellos incumplieron y comieron y desobedecieron, y a causa de eso la abuela botó las cás caras de yuca en el patio y al pudrirse se formó el lombriz “agüerosa” y con él [la lombriz], ella se estuvo como [su] marido y se escondieron [la abuela y la lombriz] de sus nie tos. Tuvieron su relación hasta que ellos los pillaron y los mataron, por haber matado de desnutrición [a] la yuca [y] a la hermanita que el abuelo les dio. Cuando ellos planeaban hacer construcción de maloca, ellos cazaban y ella, la abuela,

27
alimentaba a la niña con el marido, y ellos [los hermanos] la pillaron y la mataron por hacerle daño a la niña.
Viendo eso, el propio creador vio que eso no funcionaba bien y entonces mandó a recoger todo y quemó todo, por que el mundo no estaba funcionando como él quería sobre la Tierra. Ahí es donde se originan las sabanas de Gáaru’i (ubicadas dentro del territorio de los nejegaim jo). Después recogió todas esas cenizas, hizo un embudo y lo botó al agua, y de ese embudo se formó el pulpo Yet mobu’a . El pulpo es como el abuelo de todos los peces que hay en el agua, el segundo papá de todos es la boa; donde hay una boa, hay mucho pescado siempre.
Después el creador bajó otra vez y empezó a formar dos hijos y una hija. Ella era la mujer de la abundancia, un hijo era el “escuchador” del mundo y el otro era el que cuidaba. Esta era la tercera generación y el creador les enseñó cómo debían vivir y gobernar sobre la Tierra. Ahí aparecen otros abuelos que estaban en contra del creador: ‘asím n ba, gís n ba, níkunba, ‘añ m n ba, tujáran ba, yibam n ba. Ellos no estaban de acuerdo con el creador y querían dominar la tierra y ser los dueños, así que comenzaron a querer acabar con él. Pero, como el creador sabía más y los había creado también a ellos, sabía manejarlos y los llamó y les dio un nombre y un lugar a cada uno. Fue personificando los lugares. El creador tenía su comunidad, que formó con su palabra de vida. Pero los abue los no estaban de acuerdo. Sintieron que el creador los arrin conó y, como no pudieron con él, comenzaron a desbaratar su comunidad. Hicieron muchas malocas por todas partes sin autorización del creador y después se retiraron. El creador se quedó con sus tres hijos y no se preocupó. Siguió educando a sus hijos en la bondad y la multiplicación. Mientras tanto, los abuelos se relacionaron con seres malig nos y aprendieron cosas malas y destructivas. Con el tiempo, fueron formando cosas malas, pero empezaron a fracasar; sus hijos, nietos, ancianos empezaron a morir. Entonces culparon al padre creador diciendo que ellos vivían en bien y que él
28
les hacía eso por envidia. El creador entonces habló con sus hijos y les contó cómo los otros lo culpaban a él y que, como ellos pensaban eso, entonces él se iría, porque igual sus hijos ya estaban educados y podían quedarse solos para vivir en [el] bien. Los dejó y se fue al fondo de la Tierra. Allí formó las capas de la Tierra, dieciséis capas cada una con su nombre y allí se quedó con la hija, y el mundo se oscureció. Ya no vol vió a amanecer.
Así, en la Tierra seguían cosechando, pero, con el tiempo, ya no pudieron hacer chagra y se les acabó la comida, hasta que todos se volvieron animales, sobre todo dantas, armadillos, osos (palmero), guara, borugo, venado, etc. Ahí terminó esa generación. Pero él le había dicho a los hijos que si algún día se acordaban de él, volvería. Todo era pura hierba en la tierra y un día los hijos sacaron la hierba y la quemaron con sal, con hoja de yarumo y el olor de la hoguera llegó al creador y supo que lo estaban llamando. Entonces empezó a subir. Cada vez que quemaban el yarumo, él subía capa por capa, hasta que llegó a la segunda capa. Ahí mandó a la hija a verlos y a hablarles para ver si tenían capacidad. Ella intentó, pero ellos no le ponían atención e interrumpieron su palabra y entonces ella les dijo que, así como ellos habían sido con ella, sería la nueva gene ración, sin capacidad. Y ellos la echaron. Ella se fue donde el papá creador y le contó. Entonces él fue a verlos y amaneció. Al ver a sus hijos, les pidió agua, comida, coca, ambil, mambe, sal, etc. A lo que ellos contestaron que no tenían nada por que él se había ido y los había dejado sin nada y así seguían. Entonces el padre les pidió que llamaran a su gente para traer todo. Mientras tanto, le pidió a la hija almidón que ella lle vaba para que le hiciera algo de beber (caguana). Los hijos fue ron a buscar, pero encontraron puro rastrojo de donde salían muchos animales (armadillo, borugo, etc.), y regresaron dicién dole al padre que ya no había gente, pues todos eran animales. El padre les dijo que ellos no habían buscado bien y levantó una vía de donde empezó a llegar gente (sus nietos) trayendo todas las cosas. El padre comió y tomó y empezó a mambear. Decidió que se iría con su hija de nuevo, dejando a sus dos
29
 Avelino en la maloca de su hermano, Adriano. Fotografía de Christian Cárdenas.
Avelino en la maloca de su hermano, Adriano. Fotografía de Christian Cárdenas.
hijos con la nueva comunidad en representación de él, y por medio de ellos él le aportaría cosas a todos. Y entonces, sacó el poder de la coca, el tabaco, todas las frutas y alimentos y solo les dejo semillas sin valor y se fueron [él y su hija]. Esta nueva generación era la de los dueños, los responsables de todas las semillas de todo. Ellos se quedaron pensando cómo iban a manejar, desarrollar y multiplicar el mundo. Empezaron a pedir palabra de vida en el tabaco y coca, y empezaron a llegar animales respondiendo sus preguntas y los dos hijos les iban dando un nombre, una función, una planta, etc. Así fueron nombrando todos los animales. Las aves… Tres aves tienen un poder: la perdiz con su hoja de tabaco se tapará y nadie las va a ver; a la pava colorada también le dio el tabaco de sueño, y su nombre lo destinará a alguna persona de conocimiento [la cual adoptará su nombre] que lo hará dor mir [a la persona] y pensar en los sueños, y esa será su fun ción; el último fue el ják jáaje’e, el paujil colorado, [que] sería el pájaro de guerra y rabia. De los huesos de esta ave salió el líquido que quemó en la primera generación, el agua de can dela. El resto de animales no tienen poderes así, son seres de frío. Todas las aves son para que coman los enfermos, pues no los perjudica, mientras que los animales de sangre caliente sí y no los puede comer un enfermo. Así terminó la pava colo rada, que ve el amanecer y avisa la amanecida cuando ya viene la abundancia del verano. Los pájaros son de alegría y viven limpiando (comiendo insectos). A los micos no les dio ningún poder, pero no se dice nada al respecto. Entonces él [el creador] empezó a llamar y nadie le contes taba, cuando de pronto se le estremeció el cuerpo. Entonces el papá del cielo del otro mundo les mandó [a la humanidad verdadera, aquella a la que el creador les heredo las sustan cias y palabras verdaderas] el conocimiento del tabaco y para que no les llegará a los seres que estaban en la Tierra, mandó la puerta del cuerpo (cuando uno es pequeño que lo llaman la mollera, blandito, es esa la puerta del cuerpo), entonces por eso las palabras buenas que vienen de allá (cielo, cono cimiento) entran al cuerpo y uno las expresa. Las palabras

malas que uno expresa vienen del estómago, vientre, por que son palabras de este mundo. Entonces él se metió a la Tierra para que no lo vieran y le contestaron. Cada vez que llamaba le contestaban a un lado diferente de su cuerpo, pero no se veía nada. La última vez que llamó le contestaron al frente. El cuerpo es pecho, espalda, brazos (izquierdo y derecho), y así mismo debe ser una maloca: tiene un puerta adelante donde sale el sol, la espalda es a donde se oculta. Y eso era lo que indicaba lo que él había escuchado (norte, sur, oriente, occidente). Así se organiza el cuerpo, una maloca y el mundo en general.
Así él [el creador] se acomodó y luego empezó a alimentarse y a su hija y a sus hijos. Y encontraron una pepita pequeña y ninguno sabía cómo nombrarla. Le preguntó a la hija de la abundancia cómo llamarlo y ella respondió que le consultara a la palabra de tabaco. Entonces vio con el tabaco que era la semilla de manicuera y de ají, pero no la de coca. Entonces él le dio el ají a la hija para que ella tuviera su mambeadero y ofreciera la comida en la cocina, aconsejara a sus hijos y nietos y recibiera sus visitas. Y desde ahí es el mambeadero y donde charla la mujer. Así ella lo destinó y fue la coca cre ciendo y fue formando la palabra jách me’u’i, como cosa verde, y eso es lo que lleva la palabra cuando uno utiliza la coca, verde en la boca. Ese mismo también es el color de un paja rito que lo llamamos játy me’u y ese mismo es el nombre que tiene la maloca cuando está recién tejida con verde. Todo eso tiene diálogo.
Así fue creciendo ese tabaco, ya estaba grandecito y sacó la pri mera hoja y ella [la hija] lo cocinó. Hizo una masita sin expri mir con todo el bagazo, lo preparó y lo lamió. Cuando empezó a lamer, empezó a relampaguear por primera vez en el mundo. Entonces los seres de la naturaleza, que dijeron que iban a ser dueños de todo, se preguntaron cómo había aparecido otro ser además de ellos haciendo relámpagos. Entonces decidie

32
ron cazarlo. Así se originó la mata de coca, [a la] que nosotros [le] decimos gáñom ku, jek m ku, ‘íimako, [que son las tres plan tas principales de coca. Ahí se presentó la mata de yuca, [a la] que nosotros [le] decimos ‘at ’oján gai, compañero de la mani cuera y el ají que era como la base y el asiento de la mujer. Entonces en la mata de coca se acomodó un pajarito nano , un pajarito negrito que hace “prrr-pik”, y se sentó en la mata de coca. Y en la mata de tabaco se acomodó el tigre de tabaco, el tita’ ko, un gusano que hace la casita con palitos atravesados en la mata de tabaco y adentro de eso vive.

Viendo que a títa’ ko los demás animales lo iban a atacar con los poderes que tiene cada uno, él [títa’ ko] brinca, hace una cerca y se defiende y los desarmaba, y armaba su casa. Y de ahí viene el origen de la maloca, para qué se hace, por qué se hace el cerco: para protegerse de enfermedades y males. Y los animales siguieron atacando hasta que todo se les acabó y que daron bajo el dominio del tabaco, de la palabra del tabaco. Así terminó esta generación.
Así, después de ese tabaco se distribuyó lo que somos hoy en día, los ocaina, los andoque, los bora, los del centro (gente de centro), y ahí fueron multiplicando los clanes, los otros pue blos y más allá y más allá, y así fue ampliándose el mundo más de pa’ allá. Cada cual tiene su tabaco y yuca y cómo lo mane jan. Pero en cada territorio son los mismos animales, pero se cambia el nombre según el lugar; los insectos de sabana, rocas, montañas o planos son diferentes pero en el fondo son los mis mos. Así más o menos [es] lo que yo escuché.
33
ARTRÓPODOS
“En las bancas malas es donde se sientan los insectos, su nombre es ‘ájeba’ikaga. Entonces el origen de los insectos se da a partir del asiento malo, y de ahí sale Nikúun ba (Personaje), Sol pegajoso, (…) la hija de él tenía en su vulva alacranes, congas, cienpies, (…), un día Seséeve (personaje) ‘lucero de la mañana’, se fue a vivir con ella (…), él empezó a quemar los insectos de la vulva de ella, lo que no se pudo quemar se regó por la tierra, así se originaron los insectos”.
Eduardo Paky.

 Ciempiés. Fotografía tomada por Diego Aguilera.
Ciempiés. Fotografía tomada por Diego Aguilera.
CHI’ÉKU


Chicharra.


CHICHARRA GRANDE Fidicina sp. (Amyot & Audinet-Serville, 1843) Familia: Cicadidae ♂ y ♀ 5-7 cm, incluyendo alas Distribución: Neotrópico
Información biológica: Insectos con forma robusta que habitan en las regiones tropi cales. Se caracterizan por su aguda estri dulación (sonido que emiten), producto de unos órganos ubicados en el abdomen. Las hembras ponen sus huevos en huecos que hacen en las ramas de los árboles o arbustos. Cada especie tiene su sonido par ticular, que es emitido sobre todo por los machos y que es uno de los ruidos más potentes del reino animal. Se alimentan de la savia de los árboles.




Información etnobiológica: En las can ciones de baile de frutas, en la entrada, cuando ya está atardeciendo, se canta nom brando a chi’éku; como entre las 5:30 a 6:00 de la tarde se empieza a cantar “chi´e
chi´e”, [que] es como la despedida del día (Eduardo Paky).
Con la chicharra también se hace curación de niño gago. Uno le avisa, no lo vaya a morder, ese lo soltamos ahorita, ese no pica. Hace chillar al niño, con la chicharra grande o la pequeña, de susto es que está llorando el niño, entonces uno lo sopla. La chicharra tiene que volar, si no vuela, se tiene que traer otra, para’ que hable rápido el niño y no se enrede (Marcelino Fiagama).
36
Ilustración de Fillippe Paki (Villa Azul). Chicharras. Ilustración de Euclides Ortíz (Chukik ).
CONGA, CONGUILLA
Paraponera clavata (Fabricius, 1775) Familia: Formicidae ♂ y ♀ 2-3 cm Distribución: Desde Nicaragua hasta Brasil y Paraguay.
Información biológica: Es una gigantesca hormiga social que vive en colonias de unos 500 a 1500 individuos. También pre senta asociaciones con plantas, y construye nidos subterráneos en la base de árboles, palmas y lianas. Su picadura es muy dolo rosa, bloquea la transmisión sináptica en el sistema nervioso central de los insectos.


Información etnobiológica: Para los indí genas del medio Caquetá, esta hormiga tiene una relación o asociación en forma de trilogía entre el insecto, el hongo y el bejuco.



La hormiga conga fue castigada por bur larse de la hija de Royima (Padre Creador) y por todo el dolor que le causa a las per sonas con su picadura; así, cada año,



T FOMOGAI

durante la época de friaje mueren muchas congas; el cuerpo de éstas se pone blanco por un hongo y poco a poco se forma el bejuco de yaré… Reinaldo Ruíz, (Uitoto) (en Vasco-Palacios et al., 2008, p. 26).
Se reconocen algunas variedades de hormi gas congas. Una de esas variedades vive en un árbol y se le llama N bat fomogai que sig nifica “Conga de sol”. Con el nido de esta hormiga, formado por hojarasca, se prepara un remedio para curar el ombligo de los recién nacidos. Se tuesta y se aplica sobre la herida del ombligo del bebé (Eduardo Paky).
37
Ilustración de Fillippe Paki (Villa Azul).
N BAJEJUBE’U


Escorpión de cangrejo. Ilustración de Fillippe Paki (Villa Azul).

ALACRÁN DE CANGREJO, ESCORPIÓN




Opisthacanthus elatus (Gervais, 1844) Familia: Hormuridae ♂ y ♀ 7-9 cm (sin contar pinzas) Distribución: Panamá, Colombia y Venezuela

Información biológica: Emplean las pinzas de sus pedipalpos y su veneno para defen derse o capturar a sus presas. Se distribu yen dentro de microhábitats específicos que cuenten con las condiciones ambien tales propicias para su desarrollo, es decir, donde puedan conseguir refugio, alimento y/o pareja. Son de color oscuro de negro a marrón, sus pinzas son robustas, su cola es relativamente pequeña comparada con
su cuerpo. Pueden encontrarse debajo de piedras, troncos caídos y grietas, y suelen ser gregarios.
Información etnobiológica: Se forma a partir de un cangrejo pequeño de río. La picadura, para los indígenas, cuando se es joven duele poco, pero cuando se es más adulto duele mucho (Eduardo Paky).
38
MÉEKIRI
Luciérnaga. Fotografía de David Román, disponible en: https://pixabay.com/es/photos/ insecto-naturaleza-luci%c3%a9rnaga-5151933/
LUCIÉRNAGA

Paraponera clavata (Fabricius, 1775)


Familia: Formicidae



♂ y ♀ 2-3 cm

Distribución: Desde Nicaragua hasta Brasil y Paraguay.
Información biológica: Se caracterizan por tener cuerpo blando y alargado con ante nas filiformes o dentadas. Las hembras poseen órganos luminiscentes en la parte del abdomen en el quinto segmento, los machos en el sexto. (La luminiscencia es un proceso químico eficiente usado para el cortejo y para el reconocimiento entre sexos. Cada especie tiene su propio patrón de emisión lumínica particular, algunas especies imitan patrones para depredar a los que se acercan).
Información etnobiológica: La luciérnaga méekiri invitó a j ma’u, el cucarrón mierdero a barbasquear. Se fueron por allá a un caño lejos donde oscureció y entonces a j ma’u le dio rabia seguir allá, por lo que se había oscu
recido. Sacó un garrote y empezó a garrotiar a la luciérnaga; entonces méekiri le decía que no se preocupara, que él llevaba su linterna, pero lo que él realmente pensaba era: “no, yo me voy ahorita, yo no me varo, yo tengo mi linterna”, así que al final prendió su linterna y dejó botado a j ma’u, que trató de perse guirlo. Al intentarlo se fue estrellándose palo por palo, se enredaba, los bejucos lo jalaban. J ma’u no llegó a la casa. La historia acon seja a no ser como la luciérnaga, no ser mala amiga como ella (Saulo Mukutuy y Libardo Mukutuy).
39
DUMÓJO NEJÉKUGA / NEJÉKUME’


‘CUCHARA DE LOS CARIJONA’, MATA CABALLOS, MANTIS RELIGIOSA.







Stagmomantis sp. Familia: Mantidae ♂ 7 cm ♀ 8 cm Distribución: Neotrópico
Información biológica: Se caracterizan por tener la cabeza en forma triangular vista frontalmente, antenas cortas y aparato bucal masticador. Sus patas anteriores (el primer par) tienen espinas y están modi ficadas para sujetar a las presas (tipo rap toriales). Las hembras ponen sus huevos dentro de una ooteca espumosa. Poseen múltiples características que hacen que sea difícil localizarlas en campo, por ejemplo, el mimetismo, color y su vida sedentaria. En la cópula con frecuencia cometen cani balismo: las hembras se comen al macho desde la cabeza.
Información etnobiológica: Ese es el que tiene las dos hachas. Esa con su pri mer hacha, con esa él subió con un anda mio a bajar racimo de canangucho. Eso es lo que uno pregunta en un baile, esa es la adivinanza. Él fue el que subió y cortó racimo de canangucho, porque nadie podía subir. ¿Quién va a subir en una palma de esas? Palma de canangucho. O sea, él está subiendo, tuc tuc con esas hachas y con ese mismo corta y él cae, tuc tuc eso es que está refiriendo, mientras corta el racimo de canangucho (Marcelino Fiagama).
40
Mantis religiosa. Fotografía de LubosHouska, disponi ble en <https://pixabay.com/es/photos/ mantis-religiosa-insecto-hoja-1170776/

41
GACHÉDI’U / GIS RE
AVISPA CAZADORA, AVISPA CAZADORA DE ARAÑAS
Pepsis sp. (Fabricius, 1798)











Familia: Pompilidae ♂ y ♀ 5-6 cm
Distribución: Sudeste de Asia, África, Australia y América.
Información biológica: Avispas de gran tamaño, generalmente de color negra o azulada metálica. Se caracterizan por tener un aspecto robusto y patas largas espino sas, por su hábito de hacer vuelos cortos al ras, y también por realizar caminatas sobre el suelo, con movimientos nervio sos (muy rápidos) de antenas y alas. Las hembras utilizan arañas como presas para alimentar a sus larvas (estenofagia). Cada larva eclosionada se desarrolla sobre una sola presa. El adulto es nectarívoro, mien tras que la larva es carnívora*. La técnica general de caza de este tipo de avispas es dar saltos cortos y movimientos rápidos en el suelo para explorar el terreno y locali
zar la araña. Luego la avispa la toma y se pliega en forma tal que su abdomen queda por debajo de la araña para aguijonearla.
Información etnobiológica: Gachéri’u es la avispa más grande, que escarba la tierra, es agüerosa. Cuando ella escarba cerca al patio está “agüeriando” [agujereando] como si lo fueran a enterrar a uno. Y la otra es la que caza grillos u otras avispas, es Gis re (perso naje que cazaba con bodoquera a los monos), lo atrapa [al grillo] para sus crías, lleva lo que coge y lo mete a su nido y lo entierra (Eduardo Paky).
Cuando hay mucho mosco, ella viene, vive solitaria, entonces ella abraza y pica al ani

42
Avispa cazadora de arañas. Ilustración de J. David Román.
mal, luego lo carga y lo deposita en un hueco, le pone el huevo. En la misma “cacería” pone el huevo y además come, también se for man ahí [las crías], así viven ellas. Esa está en historia de Gisv re, cuando él todavía no tenía propiamente ese nombre, él se llamaba jeba’i’u y cuando ya se le reveló esa arma de la avispa, la bodoquera, fue que él se convir tió en Gis re. Esta avispa sí es el propio Gis re. Él mataba gente y después la convertía en danta, en tigre, en puerco. Él los moqueaba. Un día lo denunciaron ante jeba’i’u, entonces él [jeba’i’u] fue. Como él timbra, “tiririririri”, mientras él se fue a cacería, él llegó. Tenía paserado de danta, de puerco, incluso ani mal pequeñito como ratones. Entonces un día llegó jeba’i’u, y gis re, la avispa, esa venía con su catarijano de puerco, él [la avispa] venía cuando sonó un ruido, entonces él dijo: —¿Pero quién llegó a mi casa y me va a emba rrar la cacería? —dijo gis re. Mentiras que él puso un truco, y jeba’i’u estaba mirando de a raticos y entró con su cacería también. j —saludó jeba’i’u cuando entró en la maloquita de gis re —¿Quién estaba hablando aquí en mi casa? ¿Dónde se escondieron? ¿No robaron mi cacería? —dijo gis re —Oiga, compañero ¿cuántos mató?, ¿cuántos? —dijo jeba’i’u, llegó de una vez. —Oiga, ¿pero usted qué? Usted nunca anda y me ha visitado y qué pasó? Va a llover, se va a acabar el mundo —dijo gis re. —Bueno, yo vengo, gis re , yo vengo a comer donde usted. Yo vengo a comer —dijo jeba’i’u
—No, pues si yo le doy el animal pequeño que a usted no le gusta, pues usted dirá de que él me dio como animal que no quiere, gurre, culebra —dijo gis re — saque el animal que usted quiera.
—No, cómo yo le voy a sacar, no ve que usted es bueno. De lo que usted saca, pues yo lo recibo —dijo jeba’i’u
—No, saque por orden mía.
—No —dijo jeba’i’u de nuevo, porque si este jeba’i’u le sacaba comida, ese gis re lo iba a matar a él, por eso era. Jodido ese gis re, jeba’i’u no caía fácilmente. —No, yo que soy dueño de todas maneras tiene que sacar—dijo Gis re —¿Cómo yo de la pasera que usted tiene, cómo voy a sacar? Más bien démelo usted —dijo jeba’i’u.
—¡Ah, sí, es verdad! —dijo y gis re cogió una silla y la puso para bajar un puerco de allá, de esa pasera.
Entonces mientras que este gis re se fue, mientras que estuvo cogiendo ese animal, jeba’i’u de una vez lo cogió y paaaaa le dio un rodillazo al pobre gis re y lo desbarató. Lo desbarató. Porque él comía mucha gente ya, o sea, era muy carnívoro. Lo desarmó. Después quemó a gis re con toda la cacería, y ahí es donde él, jeba’i’u, convirtió a gis re en esa avispa. Por eso es que tiene casa de cemento, porque le quemaron la maloca y porque dentro de la casa de él hay mucha comida (Libardo Mukutuy).
43
ÍIKUJE
Información biológica: Las arañas látigo son un pequeño orden arácnido caracte rizado por tener apéndices espectaculares con forma de pedipalpos raptoriales y pri meras patas anteniformes extremadamente alargados. Las especies de Heterophrynus spp. se pueden encontrar en diversos microhábitats, donde es determinante que tengan una alta humedad relativa.

Información etnobiológica: Es una abuela, es una mujer. Aparece en la historia de Machútabu’a, “boa de abundancia”. Cuando él le entregó a esos dos huérfanos, a una niña que él formó a partir de manicuera (que muchos dicen de manicuera que no fue por el creador sino por ese abuelo (Machútabu’a), el que formó la primera yuca). Entonces, él quería una mujer para que le cuidara las chagras, porque ellos como hombres no podían manejar la chagra; ellos querían una mujer para que cuidara allá. Fueron y traje ron una pepa de manicuera, la rajó y de ahí salió una niña. Él entregó a la niña recién nacida para que la cuidaran allá. La niña comenzó a llorar y ellos se entristecieron, pues, como hombres, no podían cuidar a la niña, criarla. Entonces, él se dio cuenta y les preguntó: “¿qué es lo que están diciendo?” y ellos dijeron: “nosotros, como hombres, no somos capaces de cuidar a esta niña ¿cómo la vamos a cuidar?, ¿quién la va a cuidar?”. Entonces él les dijo que fueran a buscar a ese que era la abuela ‘íikujetago. Fueron a buscarla y abrazó a la niña con esos apéndi
Araña látigo. Fotografía de Diego Aguilera.
ces que tienen chuzos y le comenzó a salir le sarpullido, como infección. También fueron a buscar a la araña peluda. Todos esos insec tos fueron como las abuelas, pero como tie nen esos chuzos o pelusas entonces son las que a los niños les da[n] infecciones cuando todavía son pequeños. [A ellos] les sale sar pullido, esas abuelas son las que perjudican, por eso se llama ‘íikujetago (Eduardo Paky).
44
ARAÑA LÁTIGO, ARAÑA ESTRELLA, TENDARAPOS
Heterophrynus sp. (Pocock, 1894)






Familia: Phrynidae ♂ y ♀ 5-7 cm (sin contar patas)

Distribución: Neotrópico

45
CUCARRÓN MIERDERO, ESTERCOLERO, PELOTERO
Oxysternon conspicillatum (Weber, 1801)


Familia: Scarabaeidae
♂ y ♀ 4-5 cm



Distribución: Neotrópico.
Información biológica: Presenta un ciclo de vida en el que las larvas se alimentan de hongos, materia orgánica en descom posición y otros materiales orgánicos que se encuentran en las bolas de estiércol. De aspecto robusto, con coloración verde metálico con negro. Tanto la larva como el adulto se pueden encontrar frecuente mente en el estiércol de vertebrados o en la carroña. Este hábito permite que sean utilizados en estudios ecológicos para eva luar el estado de conservación de los bos ques nativos, lo cual quiere decir que son importantes indicadores ecológicos de perturbación antrópica. Son importantes porque aportan en diferentes servicios eco sistémicos como el ciclaje de nutrientes, la aireación del suelo, la dispersión secunda ria de semillas.

Información etnobiológica: Al comienzo, en la bocana, en la maloca del abuelo de enfriaje, ahí, hubo el primer baile. Ahí fue ron toda clase de animales a bailar y a can tar. Entonces j ma’u, como él se alimenta de mierda no más, cogió la mierda e hizo caguana y se fue a repartir[la] a las hijas de sik m tadi y sik m tago y después se fue a cantar. Ellas [las hijas dijeron] “jumm, pura mierda”. Ellas lo regaban detrás del estantillo:
“jumm viene a hacernos tomar caguana de mierda”. Todos se la rechazaban: “no, mano, ahoritica no más, yo tomé mucha caguana”, “no, ya comí, no puedo”, “no, nosotros comi mos hace rato”, “no, comida de nosotros nos llenó”. El cucarrón dio vueltas y vueltas. Al
46 J
MA’U
final ya nadie recibía, y los que le recibían regaban detrás del estantillo. “Yo mismo me la voy a tomar solo”, decía el cucarrón. Entonces llegó túumiba , el carpintero, con su caguana de sabor de mojojoy, de sabor de píipíta, “gusano tornillo”. Todo el mundo trajo su totumo y su platico. No dio ni la vuelta a mitad de la maloca, y ya la caguana se había acabado. La gente estaba esperando la de él, ahí fue cuando

dijeron “jummm caguana de mojojoy muy sabrosa, caguana de píipíta muy sabrosa”. Y pues todas las hijas del abuelo de enfriaje y la gente que estaba ahí tomaba, mientras la caguana de j ma’u, pues es de mierda, la regaban detrás del estantillo. Entonces eso es lo que cantaron esos dos, la competen cia. Entonces a la gente le gustaba más la del carpintero. Entonces de ahí pa’ acá se vino ya las canciones, estas son canciones como mirando al origen de los animales. En esa cuestión es principio que se miran con el ejemplo de los animales, por eso es que ya [existe el] aconsejo, ojo, ya [el] con sejo que le da el jefe o la madre a las hijas a las nueras: “ojo, tiene que hacer buena caguana; si va a hacer de masa de alguna fruta hay que hacer bien”, porque de pronto se pasa, se agria, la caguana queda olor de mierda, entonces, ah, ya como el principio de j ma’u, por no dar bien la ins trucción, no preparar bien el insumo para la preparación de la caguana. De ahí vienen los consejos de acá: hay que hacer bien la caguana, como de carpintero, que es sabor de mojojoy, sabor de píipíta. (Esteban Ortíz y Libardo Mukutuy).
Carpintero y cucarrón mierdero. Ilustración de Esteban Ortíz

47
(Chukik ).
Cucarrón mierdero. Ilustración de Christian Cárdenas.
R Y ’U / RÁYÁ’ÍIGAI


Ciempiés. Ilustración de Nicol (Villa Azul).


CIEMPIÉS, ESCOLOPENDRA

Scolopendra sp. (L., 1758) Familia: Scolopendridae ♂ y ♀ 25-30 cm Distribución: Neotrópico



Información biológica: Son artrópodos alargados y aplanados; su cuerpo se divide en cabeza y tórax. Cada segmento del tórax tiene un par de patas. Poseen un par de col millos o forcípulas por debajo de la cabeza que poseen glándulas de veneno. Al mor der inyectan sus toxinas para someter a sus presas o como defensa frente al depreda dor. Generalmente, se alimentan de la meso y macrofauna que vive en el suelo, pero pueden llegar a cazar pequeños mamí feros como murciélagos.
Información etnobiológica: Su picadura es muy venenosa, le dicen segunda culebra. Puede confundirse con ‘áakaba, milpiés, o con súukame’u, que es un artrópodo simi lar de poca longitud y negro que vive en los palos podridos. Este último no se debe matar debido a que sí se mata, este persi gue a quien lo mató en sueños. Ninguno de los dos antes mencionados pican, como sí lo hace el ciempiés (Eduardo Paky).

48
TÓOM / J MÚ’AI


ARAÑA PELUDA

Pamphobeteus sp. (Pocock, 1901)





Familia: Theraphosidae ♂ y ♀ 20-22 cm Distribución: Norte de Suramérica.
Información biológica: Este género de tarántula incluye grandes especies terres tres, que generalmente tienen color oscuro con matices violetas en machos adultos. Las que habitan esta región tienen color oscuro en patas y en su cefalotórax y abdomen poseen pelos rojos. A pesar de su reputación y su aspecto, la familia de tarántulas (en su gran mayoría) presenta un veneno leve, similar al de una avispa, aun que la picadura puede ser dolorosa debido a la acción mecánica de grandes quelíce ros (colmillos). Cuentan con setas urtican tes ubicadas en el abdomen que lanzan con las patas y que usan para defenderse, cuando van a mudar de piel, o en el saco de huevos.
Información etnobiológica: Se especifican por sus colores y formas (patas largas o cor tas). Pun es una araña grande peluda que vive en huecos que reciben el nombre de P n ’ikaga, “asiento de las arañas”, que son rasquiñosos, dañinos para el ser humano. También se les llama Tóom , al igual que [a] las arañas que se encuentran dentro de la maloca. Algunas que andan cerca a la orilla del río y que cargan sus huevos en el pecho, a veces andan sobre el agua. (Eduardo Paky). (Posiblemente también se refiere a arañas de la familia Trechaleidae, de los géneros Cupiennius, y Trechale, arañas que suelen vivir cerca a cuerpos de agua, y pueden pre sentar grandes tamaños).

49 P N / PUN /
Tarántula terrestre. Ilustración de Dayana (Villa Azul)
ANFIBIOS

 Abrazo nupcial, amplexo de dos ranas. Fotografía de Diego Aguilera
Abrazo nupcial, amplexo de dos ranas. Fotografía de Diego Aguilera
JAKÚKUGA
SAPO INVIERNERO, MUJER
FALSA, SAPO MANCHADO
Rhaebo guttatus (schneider, 1799)







Familia: Bufonidae

♂ 12,1-14,7 cm y ♀ 16,4-18,4 cm
Distribución: Amazonía de Bolivia, Brasil, Colombia, Ecuador, Guyana, Guayana Francesa, Perú, Surinam y Venezuela.
Información biológica: Sapo de gran tamaño, de color distintivo ocre o ama rillo-anaranjado, con manchas rojisas dorsalmente; y gris oscuro o café, con man chas redondeadas blancas ventralmente. Presenta glándulas paratiroides que exu dan y disparan una sustancia amarilla hasta un metro de distancia (Rivero, 1961), para defenderse de predadores. Se diferencia de otras especies por la presencia de una pro yección ósea que interrumpe el canto ros tral, llamada cresta precular.
52
Sapo inviernero. Fotografía de Nicolás Valdivieso.
Información etnobiológica: Con su canto “kóro kóro kóro” avisa la temporada de llu via. Ese sapo representa a esa mujer mala, la falsa mujer que llamamos jérobaik yu. Ella salió poderosa, ella decía “este es mi baile” ese de charapa, como quien dice, ella men tía, infundía daño, el veneno que ella tiene; cuando ella entra en una maloca, ella se suda. [Causa] ese aire da diarrea, vómito, tos
ferina, dolor de cabeza, en fin, lo que uno imagine que uno sufre. Por eso es que fue rechazada. Esa ya quedó como un sapo de monte. Esa señora que decimos son los per sonajes primitivos. Ya nosotros ya no somos animales, ya somos gente. Ahí es donde ella irrespeta. Eso era allá [antes], ahora es acá. Eso es pa’ que no venga esa enfermedad [la que ella causa] (Marcelino Fiagama).

53
Mujer Falsa. Ilustración de Sergio Mukutuy (Chukik ).
NAMÍTA’
RANA DE BODOQUERA
Oxysternon conspicillatum (Weber, 1801)









Familia: Scarabaeidae ♂ 4,2 cm y ♀ 5 cm Distribución: Amazonía de Bolivia, Brasil, Colombia, Ecuador, Guayana Francesa, Guyana, Perú, Surinam y Venezuela.

54
Rana de bodoquera . Fotografía de Nicolás Valdivieso.
Información biológica: Especie de mayor tamaño dentro del generó Aamerega, de color negro en todo el cuerpo con distin ción de morfos en los que varía la colo racion de la franja que bordea el cuerpo dorsalmente. Esta puede ser amarilla o verde y puede extenderse desde la base de las piernas hasta unirse en el hocico. Su piel acumula los alcaloides de las hormigas que consume. Las hembras escogen pareja dependiendo la duración y constancia del canto del macho, y depositan los huevos sobre la hojarasca; el macho los fertiliza y, después de la eclosión (a los 18 días), los recoge y los carga sobre su espalda para garantizar su alimentación y desarrollo, y los lleva usualmente a charcos fuera del territorio que cuidan con su canto.
Información etnobiológica: Los féenem ná’a dicen que pertenece a la misma familia de sapo plancho. Se le conoce como ranita de veneno para bodoquera porque él tiene en la leche veneno para dardo. Ellos tienen a los hijos en la espalda en forma de baba, ahí ellos se crían. Ahí mismo ellos ponen los huevos, ahí se revientan y ahí, cuando ya están grandes, ellos se van cayendo solos (Marcelino Fiagama).

55
Rana de bodoquera . Ilustración de Fillippe Paki (Villa Azul).
YÍTIKIRIJE








NA VENENOSA DE SARAYAKU (en ecuador)

Ranitomeya ventrimaculata (Shreve, 1935)
Familia: Dendrobatidae ♂ 1,5 cm y ♀ 1,6 - 1,8 cm Distribución: Amazonia de Colombia, Ecuador y Perú.

56
Información biológica: Rana de piel lisa muy pequeña. Dorsalmente es color naranja con tres líneas negras que se fusionan en la parte posterior con el patrón reticulado, distintivo de sus patas. El color naranja se difumina hacia la garganta y se torna ama rillo. Presentan escudos dermales en la punta de sus dedos, con discos anchos y truncados; el dedo I es igual de largo que el dedo II. Su cabeza es casi igual de ancha a su cuerpo. Aunque lo más común es encon trarla entre la hojarasca del bosque, tam bién se ha reportado que trepan hasta un metro en los árboles. El cuidado parental está a cargo del macho y carga hasta tres renacuajos en su espalda, para depositar los en bromelias o en pequeños charquitos, donde terminan de desarrollarse.
Información etnobiológica: Al final del verano avisa que el aguacero va a venir: “tiri riri tiririri”, canta llamando la lluvia. Su ova ción se da entre el término del verano y el inicio del aguacero en los pozos de agua. Eso es como un baile para ellos, poniendo huevos y bañando. Hace como un mes que ellos no se bañan, entonces van a estar con tentos porque ya va a venir aguacero. Tiene una canción de baile de frutas que contiene un consejo para los niños con hermanos. Ese sapito estaba con el hermanito andando, cuando la mamá escuchó “juepucha viene un aguacero”, entonces le dijo “agarre a su hermano, monte a su hermano, haga tun tun (alzarla y cargarla sobre la espalda) y vaya ya pa’ la casa porque viene un aguacero de namóta de vida de multiplicación, viene un aguacero muy rápido, vaya pa’ la casa”. Entonces ese no más es el mensaje de esa canción. ¿Qué quiere decir? Uno está en la chagra, “hijo gováno ‘rápido’ póngalo a tun tun a su her mano y vaya”. Entonces ya uno le enseña esta canción porque siendo ese sapito mire cómo cogió al hermanito, entonces usted cada vez que mira viento, aguacero, coja a su hermanito y a tun tun y … entonces ahí uno comienza a meterle ese consejo de cariño, de apoyo entre los hermanos. Ese sapito carga a sus crías sobre sus espaldas, como si llevase a sus hijos en un canguro terciado (Libardo Mukutuy).
57
Rana venenosa. Ilustración de Fillippe Paki (Villa Azul).
‘ÉERIJE
MUJER SOLA
Boana cinerascens (Spix,1824)
Familia: Hylidae






♂ 3,5-3,7 cm y ♀ 3,8 cm


Distribución: Amazonía de Bolivia, Brasil, Colombia, Ecuador, Guayana Francesa, Guyana, Perú, Surinam y Venezuela.
Información biológica: Su color es uni forme, verde limón un poco transparentoso con tonalidades más amarillas en su vien tre y extremidades, con puntos amarillos o blancos en todo el dorso. El dedo externo de la mano tiene membrana interdigital hasta la mitad de su longitud, mientras que los dedos II y III solo la poseen basal mente. Solo los machos presentan espinas prepólicas en la base del pulgar cuando lle gan a su adultez. Ponen hasta 800 huevos en zonas inundadas. Los machos cantan todo el año, pero la reproducción solo se da en época de lluvias fuertes.

Mujer sola. Ilustración de Juan Sebastian Boaga (Villa Azul).
Información etnobiológica: Vive por la orilla de quebradas, son comestibles (Eduardo Pakky).
58
Juanboy. Ilustración de Dayana y Juan Sebastián (Villa Azul).
Información biológica: Rana de gran tamaño y robusta. Sus patas carecen de rebordes cutáneos y los dedos de las patas posteriores tienen membranas basales. Su dimorfismo sexual no es notorio, aunque los machos reproductivos tienen brazos más hinchados. Se reporta que, en época reproductiva, suelen alejarse de los cuer pos de agua y hacen agujeros en la tierra donde se hace la oviposición de alrededor de 1000 huevos; los renacuajos se desarro llan allí por completo. Estos son carnívoros y se cree que se alimentan de sus herma nos. Sin embargo, también se reporta la oviposición cerca a fuentes hídricas.







Información etnobiológica: Informa la cosecha de chontaduro. Siendo un sapo, ese no va a comer el chontaduro, no va a chupar, pero sabe e informa la cosecha, le salen unos chucitos. “Hu hu hu”, canta. Vive en un hueco. Informa cuando viene viento, huracán. Son consumidas regularmente por las comunidades indígenas (Libardo Mukutuy y Marcelino Fiagama).
JUANBOY
Leptodactylus pentadactylus (Laurenti, 1768) Familia: Leptodactylidae ♂ 10-19,5 cm y ♀ 13,5-17,5 cm Distribución: Amazonía de Bolivia, Brasil, Colombia, Ecuador, Guayana Francesa y Perú.hasta Brasil y Paraguay.

59 NIJÁGA
RANA
ZUMBADORA DE BASSLER, RANA DE HOJARASCA DE HOCICO PUNTÓN
Chiasmocleis bassleri (Dunn, 1949)







Familia: Microhylidae
♂ 1,6-2 cm y ♀ 1,9-2,1 cm Distribución: Amazonía de Bolivia, Brasil, Colombia, Ecuador y Perú.
—Muérase, muérase para yo coger su mujer —decía, así lo estaba maldiciendo.
De eso se volvieron enemigos. Se encon traron y se agarraron a pelear, a ver quién era más valiente. Entonces ellos lucharon, como a hacer caer al otro en un hueco, y cada uno a no dejarse. B ri lo apretó con las espuelas que tiene en las tetillas y en el brazo, lo hizo chillar. El sapo plancho lo regañó, y b ri lo apretó con las espuelas.
—Suélteme, suélteme, parece usted un niño mordiéndome —sapo plancho le decía. Entonces lo soltó. Entonces sapo plancho lo maldijo a b ri, el sapo negro, por eso es que él es venenoso porque él lo maldijo.
—Mientras que yo soy el sapo frío —dijo sapo plancho de sí mismo.
Información biológica: Especie muy pequeña de piel lisa, con ojos pequeños y coloración del cuerpo café o gris oscuro. Las patas anteriores son más claras y sus dedos no tienen rebordes cutáneos; los dedos de las patas posteriores presentan membranas basales. Tiene tímpano oculto y la punta de su hocico es acuminada. En toda la región amazónica se ha encontrado alta simpatría (conviven) con especies del mismo género. Las hembras pueden poner en promedio 200 huevos.
Información etnobiológica: Sapo plan cho y b ri eran los dos primos. Un día b ri se enfermó y fueron a decirle a sapo plan cho para que fuera a curarlo y [este] lo empezó a rezar, pero en realidad lo estaba maldiciendo.
Así es que uno compara a esas generacio nes. Por eso es que le ofendió a b ri, y en el caldo de b ri va a haber fiebre, va a haber problemas; en cambio conmigo, con sapo plancho, se van a curar, ninguna mujer va a salir con un defecto. Por eso uno cura a una niña, ahí va creciendo ella y en oración le da manicuera, aguapanela, aguazucar dulce para que cuando ella se embarace, cuando va a tener la cría que no se le mire hasta allá la barriga, casi no se ve, no se nota sino cuando ya va a salir. Si uno no cura así a la niña de uno cuando es pequeña, anda así con esa barriga grande.
Después fueron peleando en un hueco de esos de coger sapos, cayeron en ese hueco y no podían salir. Entonces llamó a tempes tad y la tempestad se vino. Él hacía la bru
60 B RI
jería de él. Quebraba las ramas para que cayeran en ese hueco y así preciso se que bró una rama y cayó en ese hueco y por ese hueco él salió. Ahí siguieron en enemis tades hasta que sapo plancho mató a b ri
En otra historia se cuenta que Memé’uje , sapo plancho, parece como una hoja, todo plancheto, eso es porque le han dado garrote, lo han vuelto como masa, lo machucaron ahí donde se machuca la masa de yuca, él era gordo y lo dejaron plancheto, se vengaron de él por violar a la mujer de otro, mujer de b ri. Memé’uje tocó la vagina de la esposa de su hermano,
que estaba durmiendo, y la mano le quedó impregnada con ese olor, feo decía él.
—Ahora, si yo me siento con mi hermano a mambear y hablar de noche, pues él va a oler —pensaba sapo plancho.
Se fue a la orilla del caño y con hojarasca podrida comenzó a lavarse la mano. Ya se le acabó la hojarasca, de lavar y nada, enton ces fue y cogió la arena y con arena dele y eso nada y volvió y nada. Bueno, acabó tam bién la arena. Nada que quitaba el olor. Iba atardeciendo. Bueno, entonces se fue por el caño y encontró piedra y comenzó a sobar la manito. Por eso ese sapo tiene la mano delgada. Él se frotó las manos en la piedra

61
Rana zumbadora. Fotografía de Nicolás Valdivieso.
hasta que se le acabó el cuero, la carne, y le quedó solamente el hueso. Y cuando regresó con su hermano ya los dedos le quedaron como unas agujitas, puntuditos. Llegó donde el hermano y cuando él para darle ya la mano, pues se sorprendió.
—Pero ¿cómo?, ¿por qué sus dedos están así, sus manos?
—No, lo que pasa es que yo fui allá, cogí lombrices, se me montó ese olor y enton ces pues yo lavé y eso no quitaba, no quitaba y me fui a raspar con piedra hasta que me acabó el cuero, la carne y quedaron los huesitos —dijo sapo plancho.
—Usted sí es necio —le contestaba el hermano.
Y al sapo plancho le dio rabia y dijo que tenía que vengarse de él y lo brujeó con una infladera en la barriga. Se fue para el monte sapo plancho y duró unos quince días, y cuando regresó, al hermano estaba que se le reventaba la barriga.
—Venga, venga y conjure la barriga de su hermano —le dijo la cuñada.
—Ahhhh, sí, sí, yo sé esa oración —respondió sapo plancho.
Entonces comenzó a curar, le comenzó a hacer un rezo que decía: “muérase, muérase, para que después de que usted se muera yo pueda irme con su mujer”. Eso era lo que él decía. El hermano se murió, y ya la mujer de él, la cuñada de sapo plancho, pues informó a los enemigos de sapo plancho para que supieran que él mató al hermano, que era el marido de ella. Él le hacía señas a la cuñada para tener hijos con ella.
—¡Qué va a saber hacer hijos, usted no tiene nada, qué va a saber hacer hijos! — ella le decía.
Él decía que sí sabía y se fue a buscar juansoco y trajo la leche en una copita y la iba a usar con ella; pero ella le tiró la leche encima a él y le hizo la cría en la espalda. Por eso sapo plancho lleva las crías ahí.
Los hijos de b ri querían vengarse, cogieron a sapo plancho y se lo llevaron, lo querían matar como mató al papá. Lo chuzaron con unos chuzos, y le pregun taban cómo mató al papá. Lo llevaron a la orilla de un charco y ahí lo iban a despedazar patas arriba. Cuando ya lo iban a despedazar, sapo plancho gritó:
—¡Miren una manada de grullas arriba!
Todos voltearon a mirar, entonces, sapo plancho se tiró en ese charco, en esa hoja rasca. Por allá se escondió, lo buscaron, pero no lo encontraron (Eduardo Paky)
62
MEMÉ’UJE
Información biológica: Rana grande de color café o beige claro dorsalmente, su vientre es oscuro y tiene una forma muy particular. Su cuerpo es aplanado y ancho, su cabeza tiene forma de punta de flecha. Posee prolongaciones dérmicas en boca y garganta (órgano de línea lateral). No tiene dientes en premaxila y maxila. Durante la reproducción, la pareja nada en círculos y mientras la hembra expulsa los huevos (80 aproximadamente), el macho los distribuye en su espalda con las patas, y se embeben en la piel hasta que a las 15 semanas se desarrollan por completo y emergen. Esta especie vive camuflada en el fondo de los cuerpos de agua, entre el lodo, donde usa sus órganos extremadamente sensibles de la línea lateral para detectar sus presas y usa sus extremidades para llevarlas rápi damente a la boca.



SAPO PLANCHO


Pipa pipa (L., 1758) Familia: Pipidae ♂ 10,5-15,4 cm y ♀ 10,4-17,1 cm Distribución: Amazonía de Bolivia, Brasil, Colombia, Ecuador, Guayana Francesa, Guyana, Perú, Surinam, Trinidad y Venezuela.
Sapo plancho. Ilustración de Fillippe Paki (Villa Azul).

63
Información etnobiológica: Memé’uje fue a un baile de charapa y ahí, con una sola canción, se adueñó del baile. Él cantaba solito y nadie más bailaba, la gente espe rando turno.
—No más sapo plancho porque con esto vamos a amanecer —le dijeron.
—Bueno, listo, canten lo que ustedes saben. Yo no canto más —respondió sapo plan cho ofendido. Se fue y se escondió en un rincón.
Ahí es donde a veces mujeres que escu chan esta canción que cantó sapo plan cho se ofenden como celosas, porque es muy largo, muy aburrido. Dicen que por ahí puede haber conjura para hacer maldad a los cantores. “Parece un sapo plancho”, [con esta afirmación] lo pueden ofender si se comporta de esta manera en un baile. Mientras sapo plancho cantaba durante el baile solamente venían las hijas al lado de él. Por eso es que también ya quedaron ellos ahí pegados sus hijos en su espalda. Y por eso cuando un cantor va a cantar siem pre las primeras que llegan son la señora, las hijas o las sobrinas (Marcelino Fiagama).
Sapo plancho comenzó a volarse por el monte porque sus enemigos lo buscaban. Las grullas querían comérselo a él. Él estaba en la orilla de un lago, acostado encima de un palo y miró que volaron las grullas encima y que lo vieron, y cuando bajaron para agarrarlo, sapo plancho se metió al lago. Allá se ente rró de barro y las grullas llegaron y buscaron, revolcaron ese lago, pero no lo encontraron.
—¿Y ahora? Pues ya yo no puedo salir allá afuera porque ellos ya me están bus cando. ¿Y ahora? ¿Yo qué hago para comer? Ya no hay comida aquí, [decía sapo plancho].
Entonces sapo plancho comenzó a sacar las manos sobre el agua. Sobre ese lago venían libélulas a tomar agua y a bañarse, y las libé lulas llegaron y se pararon en la punta de los deditos de sapo plancho. Él miraba desde allá y pensaba: “Falta todavía que se paren más para matar”. Cuando ya él miraba que todas se paraban ahí en los cinco dedos ahí sí él se hundía a comer las libélulas. Y cuando terminaba, otra vez volvía y sacaba los dedos, esperaba a que se pararan y vol vía y comía. Él decía que ese que comía era guacamayo que él cazaba y cogía y hacía con las plumas del guacamayo una corona.
Por eso memé’uje tiene de enemigos a las libélulas. En un baile él hizo una corona y a las libélulas no les gustó porque él iba ofen diendo con esa corona. Entonces él cantó con su corona, la vara y su sonajera chiki chiki chiki, él iba hablando, él vino con esa corona, y todos reunidos: los sabedores, todos los del baile y en eso estaban también las libélulas y las libélulas se enojaron contra él porque, aunque él no las ofendió directa mente, solamente en la canción decía “uste des cuando comen animal botan la pluma, entonces yo sí la tengo aquí (en la corona)” a ellos no les gustó lo que dijo. Entonces él siempre iba donde el cacique de ellos con ese traje (como luciéndolo), estaba ofen diendo al jefe de ellos, de las libélulas, por eso es que no les gustó a la gente de ellos.
64
Sapo plancho se fue a un rincón de la maloca, no salió, a todo el mundo le brindaron comida, como él estaba por allá lejos, todo el mundo ya recibió, menos él…
—Bueno, ¿y el sapo plancho? (preguntaron los asistentes)
Ellos le ofrecieron, entonces las dos hijas de sapo plancho cuando le ofrecían una maraca le decían:
—Ay, papá, vaya busque.
—No, ese es baboso —él respondía. Le ofrecían entonces otra cosa.
—Sapo plancho venga busque su canastado de maní.
—No, ese es pepa de palo de brasil (Anacardium occidentale), ese es venenoso.
Todo lo rechazaba. Y cogieron bojote de ambil, entonces le dijeron:
—Sapo plancho, venga, busque este kilo de ambil.
—Papá, vaya busque —le decían sus hijas.
—No, que ese emborracha.
Todo así lo rechazó. Le ofrecieron otro canastado para él. Un canas tado de ñame.
—Papá pa’ que vaya reciba —le decían sus hijas.
—No, eso es baboso —contestaba sapo plancho.
Todo era malo. Todo. Hasta que trajeron bagazo de canangucho, el quenque, el cuncho, bagazo, entonces ahí sí, cogieron y le dijeron:
—Venga busque canastado de masa de canangucho.
—Ese sí es vida, ese es el que hace crecer, ese es muy bueno, no es dañino —dijo sapo plancho.
Y entonces él vino y lo regó, se bañó en eso y de aquí para allá, mejor dicho, se perfumó con la masa de canangucho. Por eso es que cuando cae canangucho él no falla, ahí está él, le gusta el canangucho. Con eso fue que él cayó, se bañó, se perfumó. Y es verdad, yo lo miró ahí donde nosotros nos bañamos (Marcelino Fiagama).
65
REPTILES

Atardecer sobre el chorro de Araracuara. Fotografía de Christian Cárdenas

LAGARTIJA FLACA, LOBITO DE COTICO Anolis fuscoauratus (D’Orbigny, 1837)







Familia: Dactyloidae
♂ 5,1 cm y ♀ 5,4 cm
Distribución: Bolivia, Brasil, Colombia, Ecuador, Guayana Francesa, Guyana, Perú y Venezuela.
Información biológica: Lagarto o saurio pequeño con dorso verde y pequeñas man chas cafés desiguales, vientre blanco con manchas grises o cafés. Tiene de 14 a 18 lamelas (estructuras que les permiten adhe rirse a superficies verticales) en el dedo más grande de las patas posteriores. Los machos poseen abanico gular de color rosado - vio leta o rojo amarillento con escamas blancas, el cual despliegan para definir su territorio y cortejar a las hembras. Este despliegue es acompañado por movimientos de cabeza, cola y flexiones de pecho. Es ovípara y ponen generalmente un huevo, máximo dos. Procuran mantener su temperatura corporal 1-2° C más alta que la ambiental, para man tenerse activos ante predadores o para cazar.
Información etnobiológica: Se nombra en una canción. Esa can ción es de arrullar, de acariciar a un niño, de jugar con él. Entonces está nombrando a jíiniba, lagartija de monte firme. Como él tiene la manito como carraspocita, y también juchɑ́’ y akáragai también tie nen la manito así, entonces usted alza al niñito y le coge las patitas y canta ese [canto].
JUCHÁ’I
Lagartija Flaca. Fotografía de Nicolás Valdivieso.
Lagartijas . Ilustración de Juan Pablo Mukutuy (Chukik ).
1. jíinibɑt ’ ɑño chége chége 2. ‘ɑkɑ́rɑgɑit ’ ɑño chége chége 3. ‘ɑch vɑjutɑ ’ t ’ ɑño chége chége 4. chége chége chége rum chége chége chége rum chége chége chége rum 5. jíinibɑt ’ ɑño chége chége 6. ‘ɑkɑrɑgɑit ’ ɑño chége chége 7. ‘ɑ́it vɑ́ijutɑ́’ t ’ ɑño chége chége
8. chége chége chége rum chége chége chége rum chége chége chége rum
1. Pies de lagartija grande de monte firme.
2. Pies de lagartija café. 3. Pies de lagartija verde.
4. [Sonido de la fricción entre los pies del niño].

5. Pies de lagartija grande de monte firme. 6. Pies de lagartija café. 7. Pies de lagartija verde.
8. [Sonido de la fricción entre los pies del niño].
Entonces cuando se le hace así, las patitas así (se friccionan entre sí las pal mas de los pies del bebé mientras se canta chége chége chége rum) él se ríe. Como cosquillitas. Hay veces que de tanto hacerle así él a veces se queda dor mido ahí (Esteban Ortiz).
69
SALAMANQUEJAS, TOTECAS, GECOS
Hemidactylus mabouia (Moreau de Jonnès, 1818)


Familia: Sphaerodactylidae

♂ y ♀ < 7 cm
Distribución: Nativa de África central y sur. Ha sido introducida en el oeste africano, y en algunas regiones de centro y sur américa, principalmente la cuenca amazónica.


Información biológica: Lagarto de color homogéneo. En el dorso es café oliva o gris pálido, en el vientre es blanco o lige ramente rosado. Tiene bandas o manchas marrones en su cuerpo y cola. Tiene lame las ensanchadas en la base de sus dedos, y, como característica particular, en la base del cuarto dedo de la pata estas lame las se convierten en escamas granulares. Generalmente se encuentra asociada a asentamientos humanos y rara vez en hábi tat natural. Es ovípara, pone hasta dos hue vos y se ha encontrado plasticidad en su ciclo reproductivo.

Información etnobiológica: Se convierte en sapo. No hay que reír cuando uno la mira porque puede hacer caer los dientes. A veces uno se ríe porque se le cayó la cola entonces ahí lo brujea a uno, uno pierde los dientes. Ese es dueño del canangucho. Hay que dejarle tres o cuatro gajos para él y no recogerlo todo, porque si no, la próxima cosecha saldrá biche (Libardo Mukutuy).
Salamanqueja. Fotografía de Nicolás Valdivieso.
70
MÁV
Lagartija de sol. Fotografía de Diego Aguilera.
Información biológica: Saurio de color café a verde, puede tener visos azulados. Posee una banda lateral de color verde claro de hocico a nuca que se convierte en una delgada línea café que demarca una región marrón con manchas negras del hocico a la base de la cola y se convierte en manchas sobre su cola. Vientre naranja con escamas quilladas. Tienen de 113 a151 escamas en la mitad del cuerpo y de 36 a 52 poros femorales. Ponen de 5 a 8 huevos. Son muy veloces y prefieren asolearse en horas de mayor radiación.
Información etnobiológica: ‘akáragai com parte el arrullo de “pies de lagartija” junto con j chá’i.








JAKÁRAGAI
LAGARTIJA DE SOL, LOBITO, LOBÓN Kentropyx pelviceps (Cope, 1868)


Familia: Teiidae ♂ y ♀ < 13 cm Distribución: Amazonía de Bolivia, Brasil, Colombia, Ecuador y Perú.
Lagartija de sol. Ilustración
71
por Sergio Paki (Villa Azul).
BOA, BOA MATACABALLO
Boa constrictor (L., 1758)

Familia: Boidae ♂ y ♀ < 5 mts
Distribución: Argentina, Belice, Bolivia, Brasil, Colombia, Costa Rica, Ecuador, El Salvador, Guatemala, Guyana, Guyana Francesa, Honduras, Antillas, México, Nicaragua, Panamá, Paraguay, Perú, Surinam, Tobago, Trinidad y Venezuela.
72
BÚU’A
Información biológica: Serpiente de gran tamaño, color café o beige con diseños dorsales más oscuros que se repiten en el cuerpo, en ocasiones con tonali dades rojizas hacia la cola. No tienen fosetas labiales, pero sí dos hileras de escamas grandes entre el hocico y la escama orbital; en cabeza y cuerpo sus escamas son pequeñas y lisas. No son venenosas. Durante la repro ducción se pueden encontrar varias juntas, son políga mas y ovovivíparas. Paren entre 10 y 64 neonatos, y su gestación puede durar entre 5 y 8 meses.







Información etnobiológica: Las boas son clasificadas por los féenem na’a según el sitio en el que viven o el color de sus pintas. Algunas de ellas son: jotó’ , “boa de tierra”; ‘ít , “boa roja y negra que vive en un árbol, le gusta comer ratones”; tin tín, “huevos de panguana”; t faibu’a, “boa de río”; ‘achibábu’a, o “boa verde”; gíigibabu’a, “boa de pinta amarilla”; inóbu’a, “boa de cananguchal”; yírim bu’a, “boa padre de los peces”. En historias se cuenta que de la boa se ori ginaron los ríos, por ejemplo, bu’a’ak , “estantillo de boa”, es la que figura al Río Caquetá (t emu’ai). Todos esos ríos grandes se transforman en boas, que a su vez se desmenuzan en caños y riachuelos, los cua les son boas chiquitas (Marcelino Fiagama, Libardo Mukutuy y Sergio Mukutuy).
Boa. Ilustración de Ezequiel Mukutuy (Chukik ).

73
Boa dormilona. Ilustración de Fillippe Paki (Villa Azul).
BOA DORMILONA
Imantodes cenchoa (L., 1758) Familia: Colubridae ♂ y ♀ < 125 cm Distribución: Noreste de Argentina, Bolivia, Colombia, Ecuador, Sur de méxico, Paraguay
Información biológica: Serpiente delgada y larga, de cabeza pequeña y truncada con ojos grandes y pupila vertical. Su color es café claro o beige con manchas oscuras en su dorso y vientre amarillento. Cazadora activa con una adaptación de escamas alargadas en el medio de su cuerpo dorsalmente, que le permite moverse mejor sobre las ramas. Se pueden reproducir durante todo el año y son ovíparas. Ponen hasta 8 huevos. No son agresivas, pero cuando se manipulan pueden generar un olor desagradable por la cloaca.

Información etnobiológica: LEl arrullo, de acuerdo con como lo cantó Jesús Ortíz va de la siguiente manera:
1. yíru yíru yíru yíruje ‘o ‘o ‘o






2. jɑ́n ko bechɑ́jeke dik rɑ ‘í’eneke gɑník bɑ ‘o ‘o ‘o (Sopla)
3. yíru yíru yíru yíruje
4. jɑ́n ko bechɑ́jeke dik gɑrɑ d j’ ɑno gɑník bɑ ‘o ‘o ‘o
1. Culebra, culebra, culebrita,
2. a este, a su hermano, venga y tire de su sueño.
3. Culebra, culebra, culebrita, 4. a este, a su hermano, venga y tire de su sueño.
74
YÍRUJE
IGÁIBAT




CUATRO NARICES, MAPANÁ O TALLA X



Bothrops atrox (L., 1758)




Familia: Viperidae ♂ y ♀ < 170 cm
Distribución: Bolivia, Brasil, Colombia, Ecuador, Guayana Francesa, Guyana, Perú, Surinam y Venezuela.
Información biológica: Vipérido con color variable entre oliva, café, gris y amarillo, que tiene marcas dorso-laterales que se pueden ali near casi verticalmente, en forma de “X”, o rectangulares. Cabeza de candado con colmillos móviles en la parte anterior de la boca. Tiene una foseta termorreceptora entre el ojo y las narinas. Su cola no es prensil y algunos juveniles la utilizan como carnada para atraer a sus presas. Es ovovivípara y puede tener hasta 43 neonatos. Ante su mor dedura, se recomienda llevar a la persona lo antes posible al centro médico más cercano. Los juveniles prefieren un microhábitat arbó reo, mientras que los adultos se encuentran más en el suelo y solo ocasionalmente trepan árboles.
75
Mapaná. Ilustración por Sergio Paki (Villa Azul).
GÍISIBAT RÉJE







CHARAPA DE PIEDRA



Podocnemis unifilis (Troschel, 1848) Familia: Podocnemididae ♂ y ♀ < 50 cm Distribución: Bolivia, Brasil, Colombia, Ecuador, Guayana Francesa, Guyana, noreste de Perú, Surinam y sur de Venezuela. También ha sido introducida en el estado de Florida en Estados Unidos.

76
Tortuga. Ilustración de Fillippe Paki (Villa Azul).
Información biológica: Tortuga con capa razón café oscuro y plastrón amarillo. Su piel es grisácea. Los juveniles tienen colo res amarillos más vivos, que desaparecen con el tiempo. El caparazón tiene una qui lla vertebral, es aplanado y ancho. Suelen desovar en grupos de hasta 50 hembras, generalmente durante la noche, y ponen hasta 70 huevos. El género del neonato depende de pequeños cambios en la tem peratura dentro del nido. La incubación dura hasta 150 días.
Información etnobiológica: El Sol de pie dra mandaba a tumbar un palo a los yernos. Las pepas de ese palo caían y se transfor maban en piedras y, al caer, machacaban lo que tocaran. Un gis re, el más vivo, cuando vino a vivir con la hija del Sol de piedra, hizo andamios donde caían las semillas y, al caer, esas piedras llegaban al agua y de ahí se formaban esas charapas, las charapi tas y de las astillas de la cáscara se forma ron las charapas grandes, t réje, y el mata mata, jáapa. Hay una charapa coloradita, nóoba t réje, que se usa en los bailes de cha rapa, se usa como instrumento. Casi al final de los pasos se utiliza (Eduardo Paky).

77
Tortuga. Ilustración de Sofía Venegas.
JÚPUKU













MORROCOY, MORROCO, MORROCÓN
Chelonoidis carbonaria (Spix, 1824) Familia: Testudinidae ♂ y ♀ < 51 cm Distribución: En toda Sudamérica, incluyendo Panamá. Ha sido introducida también en Nicaragua y en algunas islas del Caribe.

78
Información biológica: Tortuga de caparazón alto y semi cilíndrico, de color negro con secciones de colores amarillo, naranja o roja en el centro de las placas del caparazón. Su cabeza y extremida des también presentan escamas con estas tonalidades. El plastrón del macho es cóncavo para poder aparearse con la hembra. Puede poner de 2 a 7 huevos, en intervalos de postura de 1 a 3 meses. Se desplaza a una tasa estimada de 84 mts/h, pero en horas de acti vidad puede recorrer cientos de metros. Es considerado como un efectivo dispersor de semillas.
Información etnobiológica: Morrocoy tenía finca, tenía de todos los cultivos: piña, caimo, guacuri, júube, ahí varias frutas y no [le] dejaba [al] venado tenerlas. Ya cuando se iba morrocoy a revisar, ya no había nada. Otro día iba y ya no había nada. Y se enojó ya morrocoy. “No me deja aprovechar mi fruta ese venado, ¿qué voy a hacer?” empezó ya. Entonces invitó a la gente, a cincuenta morrocoy. “Bueno, yo vengo a invitar[los] a ustedes para matar al venado. Ese no me deja aprovechar mi fruta”, dijo. Listo. Se vinieron a lomo así las morro coy. El plan era hacer muchas chagras de morrocoy. Bueno, cada diez kilómetros se iba colocando una morrocoy y allá otra y allá otra y allá otra hasta la cincuenta morrocoy. Bueno, la morrocoy retó al venado: “corramos, no hay que mirar para atrás sino siempre para adelante. Si usted gana voy a regalarle mi finca”, le dijo. El venado estaba contento. Corrieron. Corra, corra y corra y corra. El venado preguntaba: “¿morrocoy, voy adelante?” y la morrocoy se escondía atrás, y otra morrocoy salía a la carrera. Y el venado corra y corra y corra otros diez kilómetros. Y corra y corra y ya el venado se cansó con sed, hambre con ese solazo. Así como cuando usted sube una loma así con hambre y sed. Ya se le salió la lengua y chorreaba. “Morrocoy, ya no puedo correr más” y así rogando, así rogando y bueno, no ganó nada. Quedó en la mitad de loma y se pudrió y las morrocoy esperaron que se pudriera para comer gusano. Ese morro coy es muy cochino. A él le gusta comer podrido. Y coma y coma y coma. Hasta ahí no más (Rafael Mukutuy).
Morrocoy. Imagen de libre acceso, tomada de https://commons. wikimedia.org/wiki/File:Tortuga_morrocoy_Sabanero.jpg
79
AVES
 Loro verde del Caquetá. Fotografía de Sofía Venegas.
Loro verde del Caquetá. Fotografía de Sofía Venegas.

TÁAKAGAÑ GAI


MARTÍN PESCADOR
Chloroceryle amazona (Latham, 1790)


Familia: Alcedinidae ♂ y ♀: 30 cm
Distribución: Hasta 1800 m.s.n.m., en todo el país excepto costa Pacífica al sur del Valle. Desde México hasta norte de Argentina; Trinidad y Tobago.
Martín pescador. Ilustración de Euclides Ortíz.

82
Información biológica: Los machos encima son de color verde acei toso brillante y oscuro, con estrecho collar nucal blanco; son blan cos debajo con amplia banda pectoral rufa y tienen puntos verdes en los flancos. La hembra es similar al macho, pero su banda pecto ral verde es incompleta. Están solos o en parejas y se posan en ramas en la vecindad del agua.
Información etnobiológica: Ese [el martín pescador] era cuñado de un jefe, entonces él digamos no ponía cuidado a la mujer, siempre preparaba ese quereme (usado para hacer enamorar), entonces mien tras andaba en eso a él la mujer lo saboteaba. A lo último le dijeron:
—Oiga, jefe, a la mujer hay mucha gente que están irrespetando, que están abusando —le decían.
Al final le dijeron que allá en el puerto andaba él y se fue una nieta a comprobar, y claro, allá lo pillaron. El jefe, sin embargo, no creía, entonces ahí le dijeron a él:
—Vea, abuelo, para que usted crea, vaya y mire por esa vista, que si no lo mira no va a creer; ahora mire lo que está pasando allá.
Ah, bueno, y fue a mirar. Cuando él fue a mirar, pues claro, vio a un hombre con el que tenía casado a la hija y ahí sí que a él no le gustó y, digamos, él, el jefe, para que ya lo capture [al hombre con el que estaba casada su hija], entonces le dio el poder al cuñado [de ese hombre], pero no de que mate a su hermana, sino a la persona que estaba con ella. Entonces él armó la flecha, el arpón de tijera y le dio el poder. Entonces el cuñado los dejó allá, en el río. La mujer llevaba una cuya de totumo, entonces cuando iba a bañarse lo lla maba al hombre “tu tu”, de abajo él venía. Cuando él estaba ya allá, bajó entonces el cuñado y, pucha, los agarró a esos dos y los sacó para afuera… (Libardo Mukutuy).

83
LAGARTIJA DE SOL, LOBITO, LOBÓN Kentropyx pelviceps (Cope, 1868)


Familia: Teiidae ♂ y ♀ < 13 cm

Distribución: En toda Colombia hasta los 3500 m.s.n.m., pero principalmente debajo de los 500 m.s.n.m. Sur de Texas y México hasta Tierra del Fuego; Antillas Menores y Trinidad.


Martín pescador. Ilustración de Wiston Suárez López.
Información biológica: El macho en la parte superior es gris y azul. Su garganta y lados del cuello son blancos, partes inferiores con rufo. La hembra es similar, pero con banda pectoral gris azul, bordeada por debajo de blanco. Se encuentra solo o en parejas y suelen estar posados en perchas altas.
84
TÁA’
Información etnobiológica: Ese es el joven Mu’iñame, se dice en las historias. Entonces acá ya se sentaron [quienes vivían con él] por que se fue a un territorio desconocido — ¡Que vuelva otra vez nues tro joven! —decían. Allá, donde estaba el joven, [a] él le reconoció una sonajera. Vuelva otra vez a sus territorios, su gente está recla mando, yo no te voy a hacer nada. Entonces ellos miraron —¡Ya viene! —decían. El joven que yo traje a la bocana se fue a su terri torio. Cuando él viene, la sonajera suena “ che che che ”, ese mismo viene ya con cacería para los niños (las crías), por eso se despier tan cuando suena la sonajera. Escuche, que ya viene de bajada. Ya regresó el joven Mu’iñame , va para su territorio, es una buena noticia. El sonido “ che che ” es el sonido de la sonajera que le die ron, ese ya quedó como la voz de él, del martín pescador grande (Libardo Mukutuy).

85
Martín pescador. Ilustración de Fillippe Paki (Villa Azul).
DÉENE



TENTE



Psophia crepitans (L., 1758)
Familia: Psophiidae



♂ y ♀: 45 - 50 cm
Distribución: Hasta 600 m.s.n.m. Este de los Andes, desde el occidente del Meta y río Guaviare hacia el sur. Guayanas y sur de Venezuela hasta este del Ecuador; Nororiente de Perú; extremo noroccidental de Brasil.
Información biológica: Los machos encima son de color verde aceitoso brillante y oscuro, con estrecho collar nucal blanco; son blancos debajo con amplia banda pec toral rufa y tienen puntos verdes en los flancos. La hembra es similar al macho, pero su banda pectoral verde es incom pleta. Están solos o en parejas y se posan en ramas en la vecindad del agua.
Información etnobiológica: Ese [el martín pescador] era cuñado de un jefe, entonces él digamos no ponía cuidado a la mujer, siempre preparaba ese quereme (usado para hacer enamorar), entonces mientras andaba en eso a él la mujer lo saboteaba.
A lo último le dijeron: —Oiga, jefe, a la mujer hay mucha gente que están irrespetando, que están abusando —le decían.
Al final le dijeron que allá en el puerto andaba él y se fue una nieta a comprobar, y claro, allá lo pillaron. El jefe, sin embargo, no creía, entonces ahí le dijeron a él: —Vea, abuelo, para que usted crea, vaya y mire por esa vista, que si no lo mira no va a creer; ahora mire lo que está pasando allá. Ah, bueno, y fue a mirar. Cuando él fue a mirar, pues claro, vio a un
86
Tente con escoba. Ilustración de Francisco Javier Suárez (Chukik ).
hombre con el que tenía casado a la hija y ahí sí que a él no le gustó y, digamos, él, el jefe, para que ya lo capture [al hombre con el que estaba casada su hija], entonces le dio el poder al cuñado [de ese hombre], pero no de que mate a su hermana, sino a la persona que estaba con ella. Entonces él armó la flecha, el arpón de tijera y le dio el poder. Entonces el cuñado los dejó allá, en el río. La mujer llevaba una cuya de totumo, entonces cuando iba a bañarse lo lla maba al hombre “tu tu”, de abajo él venía. Cuando él estaba ya allá, bajó entonces el cuñado y, pucha, los agarró a esos dos y los sacó para afuera… (Libardo Mukutuy).

87
Tente. Ilustración de Fillippe Paki (Villa Azul).
JÉEK / JÉEK BUYA’U

PÁJARO MOCHILERO
Cacicus cela (L., 1758)




Familia: Icteridae ♂ 28 cm y ♀ 24 cm
Información biológica: Tiene pico blanco pálido, ojos blanco azuloso; es principalmente negro con coberteras alares. La baja espalda, la raba dilla, la base y la parte inferior de la cola son amarillas. Come en todos los niveles del bosque. Anida en colonias construyendo nidos colgan tes en forma de bolsa, frecuentemente cerca a avisperos.

Información etnobiológica: Son gente de jíibi [coca], ellos eran habi tantes de él. Él tenía diferentes primos, cada uno perteneciente a un clan de esa gente. Pero como era que ese gobernaba ese jíibi, enton ces allá le quemaron la maloca de él, de jíibi. Al quemar la maloca de él, entonces esas aves [los mochileros] vinieron a instalarse aquí abajo donde que están los kiyéy m jo, por la ciudad perdida, ahí fue que ellos vinieron a instalar[se]. Vinieron los loros, los guacamayos, los mochileros, los arrendajos; vinieron y ocuparon lo otro. A lo último, el jefe de ellos se aburrió, o bueno, no se aburrió, sino que para cambiar a otro mundo él cantó, toda la gente de él le cantó a jíibi, los convirtió en pájaros mochileros, que daba “bu bu bu”, igual que un pájaro. De pronto están para eso tititikabukurubu se convirtie ron en jách me’u [la cotinga azul], miyam na’ako, jíibi jíibi ditokono dibu tokono (Libardo Mukutuy).
Pájaro mochilero. Ilustración Fillippe Paki (Villa Azul).
88
Distribución: Hasta 1500 m.s.n.m. Desde el norte de Chocó hasta el occidente y base sur-este de la Sierra Nevada de Santa Marta y sur en valle del Magdalena hasta el Tolima, base norte de la Sierra Nevada de Santa Marta, occidente de La Guajira y este de los Andes en general; occidente de Panamá hasta norte de Bolivia y Amazonas brasileño.

89
JÁCH ME / JÁT ME’U
PÁJARO
AZUL Cotinga maynana (L., 1766) Familia: Cotingidae ♂ y ♀: 19 cm
AZUL. COTINGA
Distribución: Hasta los 1000 m.s.n.m., en el este de los Andes, desde el occidente de Caquetá hasta Vaupés, y hacia el sur, Amazonía; desde Colombia hasta el norte de Bolivia y el occidente del Amazonas brasileño.

90
Información biológica: Ambos sexos poseen ojos claros. Los machos son azul cielo con garganta púrpura. Plumas externas del ala, negras; cola, azul por encima, negro por debajo. Las hembras son muy diferentes: marrón claro, escamado, y, por debajo, crema claro; plumas del pecho y vientre con cen tro oscuro con apariencia general escamado. Se percha por largo rato en el dosel del bos que, en ramas desnudas. Se pueden congre gar varios individuos en los árboles frutales, pero en general son solitarios.



Información etnobiológica: En féenem na’a es llamado jách me , mientras que en n pode es llamado Me’ . Se dice que vive en lo alto, por los montes. Se aconseja local mente que cuando se quiere [atrapar] a dicha ave con pega pega [pegamento natu ral extraído del árbol Juansoco], este tiene que ser agarrado de una manera especial para evitar que manche sus plumas con los desechos que salen de su cloaca. En histo rias aparece como alumno de Machútabu’a, el cual, por demostrar buen uso de los conocimientos que le fueron otorgados, le obsequió a jách me la pinta azul que le caracteriza. Así también se explica que ten gan representación de baile en forma de las coronas que se portan (Marcelino Fiagama y Libardo Mukutuy).

Cotinga Azul (página anterior). Fotografía de Gregory “Slobirdr” Smith, disponible en: https://commons. wikimedia.org/wiki/File:Plum-throated_Cotinga_ (Cotinga_maynana)_(16781121739).jpg

Cotinga azul (esta página). Ilustración de Esteban Ortíz (Chukik ).

91
SÍ’URAM / SÍ’URAJE
PÁJARO PÍA PÍA, POLLUELO DE MONTE
Cf Cyanocorax violaceus (Du Bus de Gisignies, 1847)







Familia: Corvidae
♂ y ♀: 34 cm
Distribución: Hasta 1300 m.s.n.m.
En general, este de los Andes, Guyana, centro y sur de Venezuela hasta el oriente del Ecuador, oriente de Perú y Amazonas brasileño.
Información biológica: Cabeza, garganta y alto pecho negros; en general, el resto del cuerpo es azul violeta y las partes inferiores son más pálidas. Suelen estar en familias o en grupos de 8 a 10 individuos. Frecuenta variedad de hábitats abiertos. Es común en los bosques de galería y hostiliza a otros animales.
Pájaro pia pia. Ilustración de Aurelio Suárez.
92
Información etnobiológica: Ese era muy abusivo. Entonces, pues tostaba la coca de otros y le echaba mucha ceniza. Por eso él falló en los principios de máchútan ba y le pusieron el cenizoso. Con esa misma coca le hicieron la maldad los animales, por eso es que él es muy abusivo. Le dijeron que el que mambea no puede recargar la coca así de ceniza porque si no se envejece, se degenera. Resulta que él, el pia pia, se envició, dicen, por eso él quedó cenizoso, Si’uraje. Por eso es que ellos no [se] bañan en el agua, sino en los polvos. También a Si’uraje le gusta mucho el chontaduro. Entonces todos los animales probaron coca de él y chorriaron, se les salía la baba cuando sabo reaban la coca, salivaban mucho, entonces la coca se mojaba dema siado. Por eso queda como consejo “no vaya a mojar mucho su coca” (Libardo Mukutuy y Aurelio Suárez).

93
Pájaro pía pía. Fotografía de Heine Rafael Gutierrez
JÍTAGACHIKU


PÁJARO ALGODONERO


Cf Tityra cayana (L., 1766) Familia: Tityridae ♂ y ♀: 20 cm Distribución: Hasta los 1200 m.s.n.m. En general al este de los Andes, Guayanas y Venezuela, y hacia el sur hasta Paraguay y el nororiente de Argentina.

Información biológica: Ave robusta, blan quinegra. Los machos son mayormente blan cos, con cabeza y cola negras. Las hembras son ampliamente rayadas de negro en la espalda, el cuello y la región ventral; espalda y cabeza color marrón. Suelen estar en pare jas o pequeños grupos posados en el dosel del bosque. Son agresivos.

Información etnobiológica: Está referen ciado en varias canciones. En una de ellas aparece pasando rápido por un puente. La canción dice de la siguiente manera:
1. j jé’año jítagáachíku j séeméne 2. j jé’año jítagáachíku j séeméne 3. báago ‘obári ‘áfatoñ k go 4. j báago ‘obári ‘áfatoñ k go
5. góova júnuga séemene divúrukú’u 6. góova júnuga séemene divúrukú’u mo‘ásiko
7. fis k n va 8. j náaka’achu fáñom nago 9. m síko ji’í nejírugo 10. mo’ásiko fis k ’in ’i 11. j jé’año jítagáachíku j séeméne 12. jé’año jítagáachíku j séeméne 13. báago ‘obári ‘áfatoñ k go 14. j báago ‘obári ‘áfatoñ k go 15. góova júnuga séemene divúrukú’u 16. góova júnuga séemene divúrukú’u mo‘ásiko 17. fis k n va 18. j mo’ásiko fis k n va
94
1. La cría de pájaro algodonero de rastrojo.

2. La cría de pájaro algodonero de rastrojo
3. de abajo vino; por el puente de palo pasaba una mujer.
4. De abajo vino; por el puente de palo pasaba una mujer.
5. Pasó rápido con su cría.
6. Pasó rápido con su cría, con nuestra cacería.
7. Venga a cargar (la cacería).
8. ¿Será que podría usted dueña
9. recibir
10. nuestro tancho con la cacería?
11. La cría de pájaro algodonero de rastrojo.
12. La cría de pájaro algodonero de rastrojo
13. de abajo vino; por el puente de palo pasaba una mujer.
14. De abajo vino; por el puente de palo pasaba una mujer.
15. Pasó rápido con su cría.
16. Pasó rápido con su cría, con nuestra cacería.
17. Venga, cargue.
18. Venga a cargar nuestra cacería.
(Página anterior) Pájaro Algodonero. Ilustración de Libardo Mukutuy. Pájaro Algodonero. Fotografía de Heine Rafael Gutierrez.
95
CHUPAFLOR. PIOJO DE TIGRE. CHUPAFLOR DE TABACO. Cf Chlorestes notata (Reich, 1793) Familia: Trochilidae ♂ y ♀: 9 cm








96
FÁIBE
Distribución: Hasta 400 m.s.n.m. En general, al este de los Andes, pero solo se conoce de unas pocas localidades dispersas río Orinoco en Maipures, “llanos de Casanare” y Leticia; guayanas y Venezuela hasta nororiente de Perú, norte del Amazonas brasileño y suroriente de Brasil, Trinidad.Paraguay y el nororiente de Argentina.
Información biológica: El macho es encima verde broncíneo y debajo, verde iridiscente. Su barbilla y garganta alta son azul iri discente. Tiene cola cuadrada, azul acero. La hembra es similar, pero con partes inferiores blanco grisáceo punteado. Inconspicuo, usualmente solitario, posado a alturas bajas o medias. Habita en bordes de bosque, en vegetación secundaria y en zonas arboladas. Información etnobiológica: Esta ave chupa flor de tabaco, se le conoce también como j kufaibe, “colibrí de tigre”, esto debido a que es aliado del tigre y le anuncia cacería. Cuando una persona va por el monte y ese pajarito baja a cada rato por el frente de uno, eso es porque el tigre está por ahí cerquita. Por eso el tigre al identificar que viene una persona se vuelve a esconder. Ese chupaflor es como el radar. Por eso se dice que es espía de tigre. Por eso es que uno no mira tigres por ahí, porque esos se escapan cuando lo ven a uno, ese es espía de ellos. Esa es la historia de él (Libardo Mukutuy, Marcelino Fiagama y Francisco Javier Suárez).
Chupaflor. Ilustración de Saulo Mukutuy (Chukik ).

97
TÚUMÍBA
CARPINTERO



Campephilus melanoleucos (Gmelin, 1788) Familia: Picidae ♂ y ♀: 36 cm
Distribución: Hasta 3100 m.s.n.m., aunque principalmente debajo de los 2000 m.s.n.m. En toda Colombia excepto el sur-occidente de Cauca y Nariño, y Guajira; Occidente de Panamá hasta el norte de Argentina y suroriente de Brasil.



Información biológica: El macho tiene la cabeza casi completamente roja con par che blanquecino, y partes inferiores (pecho y vientre) barrados. La hembra es similar, pero con una ancha franja blanca en la cara. Se encuentran en parejas o grupos peque ños. Trepan por los troncos desde cerca del suelo hasta el dosel, especialmente en árbo les muertos.
Información etnobiológica: El carpintero aparece en varias historias. Una de ellas es en la lucha por quemar el palo de gue rra. Los dos hermanos, Yaja’ y fáibe , tras derrotar al trueno (ver historia de yíruje ) con su macana decidieron hacer otro bien a la humanidad e incursionar en otra misión.
Por ello, buscaron animales aliados, el car pintero, una ardillita y otro animal. Juntos buscaron cera de abejas y luego se diri gieron al palo de guerra. Cuando llegaron, vieron muchas personas muertas, puros esqueletos y [los hermanos] les dijeron que se fueran a sus lugares y se multipli caran, que ellos ya se iban a encargar de eso. El carpintero empezó a tapar los hue cos del palo con la cera de abeja y fue el primero que cayó, se quemó el cuerpo de él y por eso también la candela se enfría en su cuerpo. El otro animal aliado fue a la misma misión y solo le faltó un hueco del árbol por tapar cuando se privó también. La ardillita terminó la tarea y los herma

98
Pájaro Carpintero. Heine Rafael Gutierrez
nos Yaja’ y fáibe le pegaron al palo de gue rra con las armas que le quitaron al rayo. Fue el segundo bien que le hicieron a la humanidad (Esteban Ortíz). El pulpo le dio el poder del hacha al carpintero y esa pinta de rojo, porque ese pulpo quedó botado por allá en el monte, entonces nadie podía arrastrarlo a él. Entonces el carpin tero buscó la manera de traer ese pulpo, pero como el cuerpo de él es pura candela, entonces pues él buscó, él probó toda clase de cargueros, pero no daban, todos se achi charraban. Después el carpintero encontró un carguero especial, y cuando el carpin tero ya lo trajo él, al pulpo no faltaba nada para llegar a la orilla, es decir, en el río en

donde él vive, en el mar, pero el carpin tero ya quería como privarse (desmayarse) con el calor del pulpo, pero lo hizo llegar y ahí sí se privó. Entonces el pulpo, como recompensa, como pago, lo cogió y le hizo quiromancia, lo sopló y le dio su poder. Antes el hacha de él era blandita, ya le dio su hacha propia para que fuera rompiendo tanta palma como quisiera y no le diera dolor de cabeza. Ahí ya el hacha de él se volvió dura (Saulo Mukutuy).
El carpintero con su canto delata a una mujer que está embarazada pero que lo oculta, e incluso brinda una premonición sobre el sexo del bebé. La historia cuenta que túumiba , “el carpintero”, pretendía a
99
una muchacha que, sin embargo, lo aborrecía a él. La muchacha en ese entonces ya había conseguido un marido, pero un día, cuando ella salió a orillas del río Caquetá, vio la cabeza de kúube, una lagartija. Por estar mirando a esta lagartija, que era otro hombre, fue que ella quedó embarazada de él. Por vergüenza de lo ocurrido, la muchacha no avisó a su marido. Sin embargo, todo había sido visto por túumiba, de modo que él le anuncia al marido a través de su canto que su mujer está embarazada. El carpintero lo hace bur lándose de la mujer por haberlo despreciado. Por esto, cuando llega el carpintero a cantar cerca a la casa, la gente se pregunta “¿quién será que está embarazada de aquí de estas mujeres?, ¿por qué túumiba está infor mando? Cuando el carpintero canta búrúmákát t , da aviso de que la mujer está esperando una niña, en cambio cuando canta péré’úkudomád t avisa que está esperando un niño. Hay una oración a través del car pintero encaminada a curar cuando una mujer sufre mucho de hemorragia, porque en [la] historia hay una mujer construida de balso que no tenía vulva y que fue construida por el carpintero. Fue cuando él reventó la vulva con su hacha que se reventó y la san gre lo bañó y le dejó esa pinta (Esteban Ortíz, Libardo Mukutuy y Eduardo Paky).

100
Pájaro Carpintero. Ilustración de Erika Nayiber Mukutuy (Chukik ).

101
TÚUMÓ’O





PALOMA DE MONTE
Leptotila verreauxi (Bonaparte, 1855)
Familia: Columbidae ♂ y ♀: 28 cm

Distribución: Hasta 2700 m.s.n.m., aunque principalmente por debajo de los 2200 m.s.n.m. Valles medio y alto del Cauca; costa pacífica en el suroccidente del Cauca y ambas vertientes de Nariño; noroccidente del Chocó, cerca al límite con Panamá; oriente hasta la Guajira y sur en el valle del Magdalena hasta el Huila; oriente de los Andes en Norte de Santander y extremo nororiental del Vichada; sur de Texas y México hasta el occidente de Perú, centro de Argentina y Uruguay; Aruna y Trinidad.


Información biológica: Paloma terrestre. Su cara más pálida, con ojo claro y anillo ocular rojo. Las puntas de las plumas externas de la cola son blancas y las patas, rojas. Se encuentra solitaria o en parejas. Camina por el suelo con mucho cabeceo.
Información etnobiológica: De acuerdo con las personas de la región, las palomas se pueden clasificar según el lugar en el que viven. La paloma que se ve en el río se llama ‘ukukuy , aquella que anda por lo alto es ním ’u, y la que viveen en los rastrojos es nam duku. Ese nam duku se originó del espíritu de la hija de yisinefa, del sol de animales, a quien el caimán comió porque él quería tener relación con ella y ella no se dejó y se le voló, se le escapó. El papá la castigó con la enfermedad de paludismo. Ahí es donde se origina el paludismo. Y la hizo enfermar, entonces pues ella, cuando la ata caba la fiebre a las seis de la tarde, enfermaba y enfermaba hasta las doce y ahí se iba a bañar, se le quitaba y luego le cogía hasta medio día. También se bañaba, se le quitaba y volvía y le cogía por la tarde y así. Entonces ella chillaba, se quejaba pues, como llamándole: “papá, mamá, venga búsqueme”, entonces ese es nam duku que cuando el caimán se la comió a ella, la mató, el espíritu quedó así, en esa paloma, y de la sangre de ella se formó ese otro pajarito que dicen
102
“pico rojo”, ese que dice “dui dui dui dui tuu, dui dui dui dui tuu” quiere decir que “ya lo comieron”. El pajarito está avisando “dui dui dui dui” que ya lo comieron, desde ahí se convirtió la sangre en él. Y ya con los gritos que ella hacía se formó ese pájaro que nosotros decimos ganakue, que dice “uuuu”, uno negrito, que parece tía tía mismo, pero tiene un copetico acá; de ella también se formó él (Eduardo Paky).
 Paloma. Fotografía de Heine Rafael Gutiérrez.
Paloma. Fotografía de Heine Rafael Gutiérrez.
BÍ’EJE
SALTARÍN CORONADO
Lepidothrix coronata (Spix, 1825)


Familia: Pipridae ♂ y ♀: 9 cm



Distribución: Hasta 1400 m.s.n.m. Costa Pacífica, este por tierras bajas húmedas; norte de los Andes hasta bajo valle del Cauca y valle medio del Magdalena; este de los Andes desde el sur del Meta, serranía de La Macarena, hasta Caquetá; sur-este de Nariño, Guainía y Vaupés, sur hasta Amazonas; desde Costa Rica hasta el noroccidente de Ecuador, norte de Bolivia y norte de la Amazonía brasileña.

Información biológica: El macho es negro aterciopelado, con coronilla azul brillante. La hembra es encima verde pasto brillante y más pálida en el vientre. Los machos for man grupos o arenas (leks) en el momento del cortejo; en otros momentos, es más fre cuente que se encuentren solos, perchados silenciosamente en un árbol con frutos. Es frecuente en el sotobosque del bosque.
Información etnobiológica: Él era el talego donde llevaba la coca machútabu’a. Él tenía la coca de bien, la coca de mal, tabaco de bien y tabaco de malo. Entonces esas cuatro plan tas él [las] manejaba. Los animales iban hasta donde él para aprender a usarlas. Entonces ese tal bí’eje era talego de ese abuelo, hoy ya cargamos es un tarro. Por eso es que él es verde, y él ganó también su título, entonces ese talego se reveló en pájaro, por eso es que él es verde [como el talego donde se llevaba la coca, que es verde]. Hasta ahí no más. Él tiene una corona azul, los machos, y el otro, las hembras, son completamente verdecitas. Mucho pajarito de esos por aquí, por ahí él anda (Libardo Mukutuy).
104
Saltarín colorado. Ilustración de Juan Sebastián Pakki (Villazul)
CHULO BLANCO, REY GALLINAZO. Sarcoramphus papa (L., 1758) Familia: Cathartidae ♂ y ♀ 81 cm
‘AÑ M MED
Distribución: Hasta 1500 m.s.n.m. Noroccidente de Chocó; este hasta región de Santa Marta; sur hasta alto valle del Magdalena y este de los Andes desde Norte de Santander hacia el sur; sur de México hasta noroccidente de Perú; norte de Argentina y Uruguay.
Información biológica: Ave grande. Cabeza y cuello desnudos, naranja, amarillo y púrpura. Ojos blancos, plumaje en general blanco, con alas, rabadilla y cola negras. Se encuentra solo o en parejas. Planea muy alto. Raramente está posado. Información etnobiológica: Existe una canción de baile de frutas diri gida a enunciar a ‘áñ m med , el rey de los chulos o chulo blanco. La can ción dice de la siguiente manera:

1. j jáafa’ika sáabo mo’áiboj bo
2. jáafa’ika sáabo mo’áiboj bo


3. jitóko jíto dú’i ‘añ m dú’i
4. jitóko jíto dú’i ‘añ m dú’i
5. mo’áy ‘añ m dú’i
6. móoniga’ gís va’i
7. mo’áy ‘añ m dú’i
8. móoniga’ gís va’i
9. gís va’i gís va’i
10. gís va’i gís va’i
1. Espere un rato mientras llega nuestro jefe, 2. espere un rato mientras llega nuestro jefe (a ver cómo se soluciona).
3. A estos los chulos los comen, 4. A estos los chulos los comen. 5. Arriba de nosotros comieron los chulos.
6. Vinieron a picar nuestra cabeza. 7. Arriba de nosotros comieron los chulos. 8. Vinieron a picar nuestra cabeza. 9. Vinieron a picar. 10. Vinieron a picar.
105

106
Entonces eso es lo que ellos están diciendo, los chulos: “deje que venga pa’ comer, deje que venga el astro de chulo, deje que venga el rey de los chulos para nosotros comer”. Sí, así como lo ordinario, así como nosotros, nosotros tenemos cacique, ustedes tienen en las universi dades su director, entonces deje que venga el director. Deje al caci que (Libardo Mukutuy).
¿Qué hace un chulo cuando muere un animal? Comer. ¿Eso qué signi fica? El chulo cuando come muerto, es un aseo, una limpieza. Todos los gusanos en ese momento no son gusanos, es el arroz, es el aliño para ellos.
Tiene historia, puro de guerra. Vienen encantos, viene pelea, de todo. Él es muy peligroso. Esa historia es de charapa. Se cuenta cuando están realizando (baile). Ellos lo tocan, ellos cuentan eso. Entonces el abuelo está contando, el tío todo eso lo cuenta, ya cuando ellos van a hacer la preparación. La hermana de los chulos es féerujemo gai. Es esa mosca grande, la madre de los gusanos. Entonces cuando, de pronto un tigre lo mató [al chulo], un animal, una boa, ellos van pasito. Ella, la hermana, va a ir a avisar allá, a la familia de ella. Al chulo rey, cabeci pelado, al grande. Entonces cuando él viene volando, por eso es que ella hace bulla, ella impulsa, suena. La mosca le avisa por que es la hermana.
“Deje que venga el jefe”. A él lo invitan cuando inicia verano, una culebra de metro, animal grande, boa grande, que el coma tres días al menos, todo el mundo se llena. No viene por chichiguas, viene de danta pa’ arriba. A él lo invitan “ah, vaya participe, vaya coma”. Y ellos [los chulos] van a sufrir al subir porque ellos no van a subir así como vino sino dando vueltas, dando vueltas. Para ellos este espacio es como una loma, uno se cansa, la altura. El rey de los chulos ‘áñ m med , él es el abuelo de ellos. (Marcelino Fiagama y Libardo Mukutuy).
107
Chulo blanco. Ilustración de Fillippe Paki (Villa Azul).
MAMÍFEROS
Churuco bebé frente al fogón. Fotografía de Christian Cárdenas.


KÍIYIGA / FÁT M J KU

ZORRO LANUDO, PERRO DE OREJAS CORTAS
Atelocynus microtis (Sclater, 1883)










Familia: Canidae ♂ y ♀: 135 cm
Distribución: Brasil, Colombia, Ecuador, Perú y Venezuela.

Información biológica: Es el único cánido endémico del Amazonas. La especie pesa entre 9 y 10 kg. Son usualmente solitarios, cazan solos o en pareja. Su hocico es largo y afilado, sus orejas cortas y redondeadas, su cabeza grande, sus patas relativamente lar gas, y su cola larga y gruesa. Su pelaje es de una coloración que va desde negro-marrón a rojizo, o gris.
Información etnobiológica: En el baile de frutas del enfriaje, las ardillas con pepa de coco machucaron y acabaron con ellos; quedó uno no más, uno negro (había de varios colores), que andaba llorando, iba de la bocana a la cabecera. De la cabecera bajaba un zorro, kíiyigamo , que iba hacía la bocana. Entonces se encontró con el escarabajo que estaba llorando. El esca rabajo se lamentaba por lo que le había pasado a su familia (los machucaron); el zorro, al ver esto, se empezó a burlar y le decía al escarabajo que parecía una viejita llorando. El escarabajo no quedó contento con el zorro. Luego de esto, kíiyigamo se regresó para la cabecera donde había un lote de helechos, donde el zorro dormía,
110
Zorro lanudo. Ilustración de David Román
y ahí se quedó dormido. El escarabajo que lo había empezado a perseguir lo fue a encontrar en ese montón de helecho y se le metió por el rabo del zorro. Como el zorro estaba dormido, no se dio cuenta; el escarabajo comenzó a desbaratar las tripas del kíi yigamo, hasta que se murió y pudrió. De esa pudrición salieron las crías del escarabajo y se multiplicaron. También hay un zorro que se parece a una guara, se le llama Fát m j ku. Tiene un pelaje pare cido a la de la guara (Eduardo Paky).

111
MAICERO



Sapajus apella (L., 1758)



Familia: Cebidae ♂ y ♀: 35 - 49 cm
Distribución: Argentina, Brasil, Colombia, Ecuador, Guayana Francesa, Paraguay, Perú y Venezuela. Se encuentra en toda la Amazonía y Orinoquía colombiana, en el departamento del Vichada y penetrando en el río magdalena hasta el Huila.
Información biológica: Vive en grupo y tiene comportamientos socia les como la cooperación y la formación de coaliciones. Es uno de los pocos primates del neotrópico que descienden de los árboles y se des plazan por el piso. Los machos tienden a ser más robustos que las hem bras. El pelaje del cuerpo varía entre café oscuro y claro y marrón rojizo.

Información etnobiológica: Había uno que se llamaba Túuse y él tenía una hija y un niño; el otro era un joven que se llamaba Fóobo’i. Él vivió con la hija de Túuse. Entonces él lo dejaba para hacer sus diligencias en el negocio de hachas. Mientras eso, el papá (el suegro) lo alimentaba. Él cazaba con ese tubo de chonta, sacaba pescado. Luego los testícu los de él se formaban como hormiga [tomaban la forma de hormigas], y pues él mismo se quemaba y la ceniza lo sacaba como sal, y los mez claba [la sal] con jugo de hormiga y cocinaba los pescados, y comía eso, y no les daba a la hija ni al hijo. Así vivían, nunca le daba a la hija, hasta que la hija tuvo un hijo llamado Fóobo’i. Él siempre en sus dili gencias. Un día, mientras él cocinaba su pescado, ella fue a mirar el ají del papá que tenía pescaditos y ella se lo comió. Entonces, cuando llegó el papá con el pescado que él tenía, con hormigas y la sal, cuando él miró la olla, la hija lo había vaciado. Entonces le preguntó a la hija:
Mono maicero. Fotografía de Max Pixel, disponible en <https://www.maxpixel. net/Monkey-Animal-Portrait-Animal-World-Mammal-Primate-3134166
112
J
MÚ’AI
—Hija, ¿usted se comió mi ají?

—Sí, usted come pescado al lado de nosotros y usted nunca nos brinda.
— Está bien. Si quieren comer, coman.
Entonces así hacía la hija, traían los pescaditos de la trampa, y luego él le hacía como un embudo y sacudía los testículos y cogía las hor miguitas y lo amarraba [a las hormigas], luego sacaba leña y él se que maba. Cuando ya se quemaba bien, se levantaba y la ceniza la sacaba como sal. Así ella siguió comiendo con el hijo y con el hermanito. Con el tiempo, la hija se fue enfermando, apestando. Se enfermó. Ya ella no podía caminar, y el niño que ella estaba criando también
se estaba enfermando. Cuando ella se vio muy mal, él le dijo:
—Será por comer pescado de quebrada. Vamos al Caquetá a comer pescado de río grande.
Entonces él iba nombrando [diciendo], como se iba quedando la hija, entonces le decía:
—Vaya espérame en la quebrada de Banco.
Ella estaba muy flaca. Él se iba y revisaba la banca y le daba de comer. No la curaba, y así le decía:
—Vaya espérame en la quebrada de Yarumo. Ella se iba quedando pálida. Llegaba allá, le daba de comer.
—Vaya espérame en la quebrada de kama’i (terrón blanco).
Ella estaba ahí blanca, pálida…
—Vaya espérame en quebrada de t ku’i (que brada podrida),
En ese pedazo, el hermano ya no pudo y se convirtió en animal, en mono. Y ella se fue con el hijo a la quebrada t ku’i. Ahí se murió, se pudrió. Entonces, cuando la hija se pudrió, se regresó para la casa, y cuando llegó el marido ya no la vio. Entonces dijo:
—¿Dónde está su hija?
—No sé para dónde cogieron.
Y él se fue a revisar, él se fue mirando, iba revisando las trampas, el pescadito; y, a lo que terminó, fue a buscar hojas e hizo una copa. Se sacó los testículos, los sacudió y los amarró. Fue por leña, prendió, se acostó
y se quemó hasta que salió ceniza. Cuando se apagó se levantó; “hm, así es que él hace”. No quiso hacer nada. Luego él estaba ahí cuando se dieron cuenta otros persona jes como el perico, el chulo (gallinazo). El perico, al darse cuenta que él hizo pudrir a la hija, se fue a contarle a la hija de Túuse:
—Yo vengo en busca de tu hija.
—Ah, entonces está usted burlándose de mí. Ustedes fueron los que le hicieron mal a mi hija y ya no existe, y usted como bur lándose viene a pedirme a mi hija. Pues si usted [la] quiere a ella pues vaya a bus carla— dijo Túuse. —Bueno— dijo el perico.
Cuando la vio podrida, llena de gusanos, el perico comenzó a alimentarse de gusa nos que se alimentaban del cuerpo, y luego se fue sin hacer nada. Después de eso, el chulo (el gallinazo) fue y le dijo lo mismo que le había dicho el perico: —Yo vengo a buscar a su hija para vivir con ella. —Ustedes fueron los que le hicieron daño a mi hija y por eso fracasó mi hija y ahora vienen a burlarse de mí, pues si usted quiere, allá está ella, pues vaya a bus carla— Túuse respondió.
Y se fue el gallinazo viendo la pudrición, los desechos, y empezó a recogerla, todos los desechos; y luego él consiguió ese car guero de cargar niños que se dice gáache, y metió los desechos y se fue; luego él pidió el ají de las estrellas (pakik de, un ají para curar), cuando en el camino él escuchó
114
lamentos, “yo quiero tomar”. Cuando [ella] quedó [casi] como una persona dentro del carguero, como [cuando alguien está] cargando un niño, cuando iba acercándose a una quebrada, dijo: —Usted quiere tomar, ya vamos a llegar a una quebrada.
Al llegar lo bajó [el carguero], “yo quiero tomar, tengo sed” y se vol vió como con vida. Entonces al bajar cogió el ají y se lo metió por la boca, por la garganta, la hizo vomitar, la hizo tomar agua, hasta que se convirtió de nuevo en mujer. Se arregló: [él] le puso las piernas de piña, las nalgas de totumo, y luego la cabellera; quedó una mujer bien alentada. Él la llevó a la casa y el chulo tenía su propia mujer y le dijo: —Ya trajo la mujer. Usted fue a buscar esa pudrición, no se me acerque con esa mujer podrida.
—Ella está bien. No está podrida. Ya es persona— y así ella entró.
Cuando el papá de ella se dio cuenta que el gallinazo la convirtió en mujer, comenzó a decir que “por qué se llevó a mi hija sin per miso”, y la hija se dio cuenta. La gente comentaba que el papá iba a buscarla, a reclamarla. Al escuchar eso, ella le dijo al gallinazo que sacara leña de puro palo duro, para ella atizar el fogón, leña de cora zón. Así estaba preparada para cuando vino el papá. Cuando llegó el papá, le dijo al gallinazo:
—¿Por qué usted trajo a mi hija sin pedirme permiso? Y ella cogió un trozo de esa leña:
— ¿Cuál es su hija?, si usted tuviera hija, usted no me hubiera hecho eso a mí. Luego cogió al papá a garrotazos, lo mató y lo echó al agua. Y se fue por allá, y otro grupo la recibió, así él iba yendo hasta que lo echaron para abajo. Entonces ese es el cuento del mono, es como la enfer medad de desnutrición que [se] formó para los mayores, no para los niños ni para los jóvenes. Por eso es que cuando van a curar a un enfermo tienen que saber qué clase de desnutrición tiene porque hay muchas formas de desnutrición, pero siempre hay tratamiento con ají, tucupí… (Eduardo Paky).
115
VENADO, VENADO CENIZOSO
Mazama nemorivaga (Cuvier, 1817)



Familia: Cervidae ♂ y ♀ 75-105 cm Distribución: Desde Panamá hasta la región costera y amazónica de Bolivia, Brasil, Colombia, Ecuador, Guayana Francesa, Surinam y Venezuela.


Venado. Ilustración de Fillippe Paki (Villa Azul).


Información biológica: El pelaje dorsal tiene una coloración de café grisáceo a marrón achocolatado, característica diag nóstica de la especie. Está uniformemente coloreado o ligeramente manchado de ama rillo. No existe un contraste fuerte entre el pelaje del cuello y el del cuerpo. Solo los machos presentan cornamenta. Tiene un rostro alargado. Se registra en la zona tro pical y bosques húmedos, en desiertos y matorrales xéricos. Es solitario y presenta comportamiento territorial.
Información etnobiológica: Ese es el ori gen del canasto. En un mito se dice que era el canasto del sol de piedra, Gísin ba, [que] es el canasto para sacar coca. Cuando a los yernos les hacían la pregunta “¿dónde está su canasto?”, él decía “ahí está”. Ellos bus
caban por ahí un canasto y volvía y le decía “¿dónde está?”, “¡ahí está!”, decía [Gísin ba] no más. Y él vivía ahí acostado y si no lo podían encontrar, entonces pues se levan taba, les pegaba un garrotazo, los mataba y se comía a los yernos. Ahí es donde se ori ginan las cuestiones, que antiguamente cas tigaban a los yernos que vienen a tumbar, que descargan los estantillos, pero no fue ron originados, esos [los yernos y los gisi niiba] son los que originaron todo eso, la forma de vida. Entonces, cuando él [los yer nos] le dijo: “¿dónde está?” “ahí está” [con testó Gísin ba], y él [los yernos] lo miró ahí, estaba acostado. Cogió y le pegó una patada, lo volteó y quedó fue un canasto. Entonces de ahí se origina ese jíiba’i que decimos nosotros (Eduardo Paky).
116
JÍIBA’I
BORUGA, BORUGO


Cuniculus paca (L., 1766)




Familia: Cuniculidae ♂ y ♀ 60-80 cm
Distribución: Argentina, Bolivia, Brasil, Centroamérica, Colombia, Cuba, Ecuador, Guyana, Paraguay, Perú y Venezuela.




Información biológica: Posee pelaje corto y áspero que tiene como fondo el color cas taño rojizo a castaño o café oscuro, el cual presenta de 3 a 5 bandas blancas desde el cuello y de forma prácticamente horizon tal, generalmente interrumpidas, que for man hileras de manchas. Presenta hocico chato con varias vibrisas cerca de la nariz. Utiliza madrigueras de huecos en tierra o de árboles caídos para el sueño diurno.
Información etnobiológica: El grande es el espiritual. Entonces [es] la boruga que nosotros le llamamos como la “agüerosa”, la grande. Uno no la ve todo el tiempo. Cuando uno quiere hacer agüero uno sí lo ve [al borugo] del tamaño de un cerrillo, júrubatáak . Cuando él está haciendo tro
nar hace un sonido [onomatopeya simi lar a un trueno], pero que tiene origen en la tierra no en el aire. Otro es llamado jakutáak (borugo de maraca) [y es] más grande, de 8 kg. [Hay] otro más mediano (6 kg), el común y corriente ( táak ). Otro negrito pequeño (3 kg) [es llamado] ratón de yuca, ján gaitáak ; y otro parecido, colo radito, gaim jetáak . Hay uno que se formó de lombriz, otro que se formó de maraca [la pepa del cacao]. A [propósito de] ese tal [se cuenta que] Gis re a la mujer le tiró una maraca, y esa maraca se pasó [es decir, la mujer se la comió], y de ahí es donde la mujer tiene el aborto, después de eso ella quedó en embarazó y nació esa boruga jakutáak (Eduardo Paky).
117
TÁAK
Borugo. Ilustración de Yinelkin Paky (Villa Azul).
’ÚNUBA’ KO / MÉNIM RIT DAKAJE /



N FÁIJ KU
Información biológica: En Colombia se encuentra en todo el territorio, entre los 0 y los 3200 msnm. Su pelaje es corto, de coloración amarillo rojizo en los costa dos y el dorso, de color blanco en la parte ventral y pálido en la parte inferior del hocico, la mandíbula y la garganta. Tiene manchas negras en forma de rosetas. Se pueden encontrar individuos con colora ción negra. Es estrictamente carnívoro y territorial. Está asociado a hábitats húme dos próximos a cursos de agua y cobertura vegetal densa.





Información etnobiológica: Existe tigre mariposo de diferentes clases, jebám ’unubaj ku . El tigre de manchas grandes y

TIGRE, TIGRE MARIPOSO, JAGUAR
Panthera onca (L., 1758)



Familia: Felidae
♂ 241 ♀ 147 cm
Distribución: Desde el sudeste de Estados Unidos hasta el sudeste de Argentina.
el pecho blanco es unuba’ ko. El de pintas muy finas es ménim rit dakaje. Ese es el que le gusta andar con los puercos, por eso se llama así “que come los puercos”. N fáij ku o n fáituraka es el propio tigre de agua. Es parecido como al tigre mariposa, así como el jaguar; es parecido, así de grande mismo, es bien amarillo. Tiene una pinta como un poco negrito, pero bien amarillo. Tiene la piel como de lobo, como la nutria, bien lisa. Las manos son como de lobo, así como de pato, pero pues es lo mismo que un tigre, él sale a tierra. Otro [es] t ’em maraga. Esa pala bra quiere decir como “arepa de danta”. Él es el jefe de todos los tigres y el compañero del tigre n fáiturakaje (Eduardo Paky).
118 J KU / JEBÁM ’UNUBAJ
KU /
Tigre mariposo/Jaguar. Ilustración de Sofía Venegas.
NÓOBAT FAI’U/ NÉEFIM T FAI’U

TIGRE COLORADO, TIGRE COLORADO DE ACHIOTE, TIGRE COLORADO DE ARDILLA
Puma concolor (L., 1771)











Familia: Felidae
♂ 200 ♀ 230 cm
Distribución: Desde el norte de Canadá hasta el sur de Argentina y Chile.
Información biológica: En Colombia es el segundo félido de mayor tamaño. Su pelaje dorsal es uniforme, con coloraciones que varían desde marrón grisáceo claro a marrón oscuro; su pelaje ventral es color crema. Únicamente los juveniles y las crías presentan manchas. En Colombia se distribuye desde el nivel del mar hasta los 4100 m. Tienen una naturaleza sexual de tipo polígama (tienen varias parejas reproductivas a lo largo de su vida) y son solitarios. Habita en bos ques húmedos, bosques secos, bosques andinos, sabanas, humeda les, desiertos y páramos.
Tigre colorado. Ilustración de Fillippe Paki (Villa Azul).
119
JÁMANA

BUFEO

Inia geoffrensis (Blainville, 1817) Familia: Iniidae ♂ y ♀: 270 cm



Distribución: Cuenca del Amazonas, Cuenca alta del río madeira y la cuenca del Orinoco.

Bufeo. Imagen de libre acceso, tomada de https://com mons.wikimedia.org/wiki/File:Sousa_chinensis_head.jpg


120
Información biológica: Tiene una cabeza prominente y un hocico largo. La coloración de estos varía y depende de diferentes facto res. Se encuentra distribuido en las cuencas de los ríos Amazonas y Orinoco. La elección de hábitat para los delfines rosados varía de acuerdo con periodo hidroclimático (aguas bajas, de transición y altas) y de la oferta alimenticia. Por esto se ven obligados a migrar de forma estacional.
Información etnobiológica: En el origen de todos los loros se men ciona al bufeo: casi al final del segundo origen, el abuelo de cen tro que dice baño’otadi, “el abuelo de tabaco de vida”, consiguió una mujer que lo empezó a odiar por [su deseo de estar con] otro. Para pillarlo, el abuelo formó esos bailes de frutas para rechazar los orí genes [los cuales son asociados con lo malo, de modo que los bailes son maneras de enfrentarse a ello]; entonces cuando él (baño’otadi) los encantó, es que se forma[ron] y se origina[ro]n los bufeos, y los vivientes que iban al baile fueron los que se convirtieron los loros (loros del chorro).
Hay tres clases de bufeo: el rojo como que lo llaman “bufeo de cama rón”. Ese primero fue camarón y se convirtió en bufeo. El otro es el grande, negro, como medio negro. Ese es el que yo dije que lo encantó es el abuelo de centro que lo encantó para saber con quién era que la nuera [su nuera] tenía relaciones y le dolía porque no le quería al hijo, entonces él los pilló y lo encantó, ahí se encantaron esa generación [es decir, hizo que se convirtieran en animales] y se formó el bufeo grande pero que no es rojo, sino oscuro. Y está el pequeño, peca’o. Él espanta a los pescados cuando uno está alumbrando las orillas, le ayuda a uno a espantar los pescados hacía la orilla para uno pescarlos. Para a hacer eso [es decir, lograr que peca’o ayude a pescar], pues cuando él sale, cuando está boyando, que está por ahí al lado de uno, el primer pes cado que [uno] coja pues [se] lo tira a él para que él coma, para que lo ayude a espantar (Eduardo Paky).
121
JÉEJ

OSO PALMERO, OSO CABALLUNO, OSO HORMIGUERO








Myrmecophaga tridactyla (L., 1758)
Familia: Familia: Myrmecophagidae ♂ y ♀: 200 cm
Distribución: Desde el norte de Argentina, Bolivia y Paraguay hasta los Andes ecuatorianos y colombianos, y Honduras.
Información biológica: Cabellos café oscuros o negros cubren la mayor parte del cuerpo. Estos animales tienen rayas negras en forma triangular que se extienden desde atrás de la oreja y la mandíbula hacia las extre midades anteriores, llegan hacia las posteriores y terminan en la mitad del cuerpo. Las especies neotropicales se encuentran en elevaciones bajas. Tiene un cráneo largo y tubular con un rostro alargado que le per mite alimentarse de hormigas y termitas. Su lengua se extiende hasta 60 cm de largo. Son solitarios.
Información etnobiológica: Tiene varios orígenes: 1) árbol de gue rra; 2) el que funciona como poder de comercio; 3) el que se ori ginó [a partir de] la suegra de Gis re con la hija [pues en un relato se cuenta que Gis re transformó a su suegra e hija en animales, una de ellas en eso hormiguero]; y 4) el personaje que se metió al fondo de la tierra.
[Hay un] cuento para el niño llorón, que se enoja por la comida: Gis re tuvo un niño. Ya el niño era grandecito, se lo dejó con la suegra, y [a] ese niño le gustaba comer cabeza de loro, lo flechaba [Le dis paraba con una flecha]. Entonces, para que la suegra le diera de comer, flechó a la lorita. La abuela le cocinaba, y el niño comía pura cabecita. Así pasaba todos los días, hasta que un día, mien tras el niño estaba jugando al medio día, la abuela lo llamó: “nieto venga a comer”; a lo que el niño respondió que no quería comer, que más tarde iba a comer. Entonces, la abuela se comió la comida del niño (la cabeza del loro).
Ya en la tarde, como a las seis, siete de la noche, el niño le preguntó a la abuela dónde estaba su cabeza de loro, a lo que ella respondió que, como no quiso al medio día, ella se lo había comido. Entonces el niño se enojó, lloraba, se revolcaba en el suelo. La abuela le decía que, como él no quiso, ella se lo comió: “no llore, cálmese. Mañana papá va a traer más”. Él niño seguía renegando. Ya entre
Oso Palmero. Fotografía de PublicDomainPictures, disponible en <https://pixabay.com/es/photos/ oso-hormiguero-animal-zoo-mam%c3%adfero-20055/
123
las 8:00 - 9:00 p.m. seguía llorando el niño, entonces la abuela se cansó y le dijo que se fuera a llorar al patio. Lo jaló del brazo y lo dejó en el patio: “llore allá afuera”, y le cerró la puerta. Luego la abuela fue y se acostó y se quedó dormida. En ese momento bajó el que antiguamente se decía que se robaba los niños, Subára, per sonaje que dicen que tiene los testículos pegajosos. Cuando quiere atrapar a un niño abre eso [los testículos] como una atarraya y lo atrapa. Y así atrapó al niño, quien estaba sentado llorando, y se lo empezó a llevar.
Entonces, mientras se lo estaba llevando, el niño empezó a gri tar “abuela, abuela, ¿qué animal será lo que me está llevando?”. La abuela se levantó, abrió la puerta, y vio como se lo estaba lle vando. La abuela le dijo: “muérdalo”. El niño respondió que ya lo había hecho, pero que era muy amargo. Y así se llevó al niño. Allá arriba lo comieron la gente de él, que son las estrellas. La abuela de tristeza se puso a llorar. Al otro día venía el papá con el lorito, y ya no vio al niño, no dijo nada. Pasó el tiempo y le preguntó a la suegra, “¿y el niño?”. “No, yerno, el niño ya no está en la casa”, dijo la suegra, “se la pasa jugando; él llega tarde, de noche”.
Así pasaron los días con la misma situación, hasta que el papá se quedó pensativo de la situación, se dio cuenta y empezó a lamen tarse. Luego fue donde la mujer y le comentó que la abuela estaba renegando que el niño no tiene nada que comer, “entonces mañana vamos a madrugar allá hacia el centro a barbasquear en la quebrada para llevarle pescado al niño, hay que madrugar a hacer casabe”. Temprano se levantó la mujer, hizo casabe, arrancaron barbasco y se fueron para el centro, a la quebrada. Recogieron el pescado que obtuvieron y comieron. El papá del niño luego le dijo a la mujer que iba a bajar un poco para coger más pescado, pero en realidad fue y cogió todo lo que es rasquiñoso, y [a] eso lo convirtió como si fuera pescado de quebrada. Ese pescado lo amarró envuelto en hojas y le dijo a la mujer “áselo bien esto para que usted [lo] lleve a su mamá”. Luego él se fue a mirar hacia arriba de la quebrada para seguir cogiendo esas cosas rasquiñosas y convirtiéndolas en pes cado (picalón, dormilones, etc.). Luego de asarlo se fueron.
124
En el camino, el papá del niño le dice a la mujer que entregue ese pescado asado rápido y que se regrese, y “si la abuela te ofrece de comer ese pescado, no lo recibas”, decía el papá. Él se fue para la casa a esperar a que la mujer entregara eso y se regresara. La mujer y la mamá de ella se pusieron a comer dicho pescado. Como se demoró la mujer, él fue a buscarla a la casa de la suegra, y cuando las encontró, las encontró bañadas en pura diarrea, “yo le dije que no comiera eso”, “ahora me va a tocar hacer esto”. Cogió el mata frio [una fibra de este árbol] e hizo la cola [una artificial] de [este material] para las dos. El ñame que le ofrecía al niño, lo puso en los brazos y en las piernas. Luego con la “cuya” lo puso en la trompa [poniendo esa cuya en la boca, para que se asemejara a una trompa larga], con lo que ella filtraba esa hormiga ácida para hacer ají, ese embudo lo puso para hacer la cabeza, y luego las orejas la hizo con hoja de tabaco. Y luego le ofreció [Gis re a su suegra] el carguero del niño que cargaba el abuelo; [se] lo atravesó en el pecho, él lo espantó y ya lo transformó en oso palmero, corriendo y lo per seguía, echando pedos, diarrea, luego lo sacó por la puerta hacia afuera. Entonces ahora se llamará viejo, oso palmero que le dicen, jéej mobe . Entonces así fue que se formaron ellos, porque le hizo comer al hijo, por fue que Gis re lo castigó y luego lo formó a eso a la suegra y a la mujer [a ambas las volvió osos hormigueros]. El nombre del oso palmero es jéej . Cada oso tiene su origen.
Las libélulas de alas amarillas tienen el mismo nombre, jéej (Eduardo Paky).
125
’E
DANTA




Tapirus terrestris (L., 1758)

Familia: Tapiridae




♂ y ♀: 212-229 cm
Distribución: Desde Colombia hasta el norte de Argentina, Brasil, Guyana, Guyana Francesa, Perú, Surinam, Venezuela en tierras bajas y región amazónica.
Información biológica: Los tapires son especies robustas de cuerpo cilíndrico y cuello grueso con extremidades relativamente cortas. Las extremidades posteriores presentan tres dedos y las extremidades ante riores tienen un cuarto dedo más pequeño que los demás. Tiene una cabeza grande con una proboscis móvil. Los Tapires presentan tama ños de población bajos. Para su supervivencia dependen altamente de la cobertura vegetal, para alimentación, refugio y protección contra depredadores. Durante las fases tempranas de desarrollo la madre deja oculta a las crías en la vegetación mientras forrajea. Las crías presentan una coloración de líneas y puntos que desaparece a medida que cre cen. Cumplen un papel importante en la dispersión de semillas y como fuente de alimento para los carnívoros.
Información etnobiológica: Según las personas, existen diversas variedades de dantas, cada una con su propio origen. Algunas de estas variedades fueron encantadas ahí donde se formaron los sala dos y cananguchales, ahí se formó un grupo. A otro grupo los encan taron en el agua y se convirtieron en bufeos. En tierra fueron dantas, pero en el agua esa gente ya se encantó en bufeos. Otro origen de una variedad de danta viene de una historia. El hijo se comía de la chagra de la nuera. El papá de él lo transformó en danta kajaot ’e, esa es una danta con pezuñas grandes como pepa de yugo (Pouteria cf. cladantha). El papá lo formó a él de la pepa de yugo. Otro grupo

126
T
de dantas se transformaron cuando el nieto de centro les ofreció a todos esos que mambearan, entonces de esa rabia se metió al fondo de la tierra y el mundo de oscureció, ahí se encantaron esa genera ción: nikujet ’e, miseset ’e (con la punta de la oreja blanca), gomot ’e, y madamat ’e. Estos son los que cuando uno abandona un lugar, los reemplazan, les gusta comer los yarumos (Cecropia peltata), hoja de Cocuy (Macoubea guianensis), hoja de caimo (Pouteria caimito).
Otras variedades de dantas son: jayaot ’e, jadiot ’e (Blanca como el algodón. Vino de arriba, cuando el algodón cayó esta se formó con él), gachiot ’e (de Higuerón), ga’im jot ’e (dicen que es la danta propia, pequeña y de color rojizo).
El Río Caquetá es conocido también como t ’emu’ai ‘río grande de Danta (Eduardo Paky).
 Danta. Ilustración de Fillippe Paki (Villa Azul).
Danta. Ilustración de Fillippe Paki (Villa Azul).
FÁAFAIBA






CERRILLO

Dicotyles tajacu (Cuvier, 1816) Familia: Tayassuidae ♂ y ♀: 72 cm–114,5 cm Distribución: Desde Norteamérica en Arizona hasta la región amazónica de Bolivia, Colombia, Ecuador, Paraguay y Perú. Los llanos y las tierras bajas de Guyana, Surinam y Venezuela. También en las Islas de Trinidad y Tobago.

Información biológica: Constituyen parte importante de la biomasa animal terrestre en los bosques neotropicales. Presentan una franja de pelos claros que se extiende en forma de collar alrededor de los hombros. Presenta comportamiento gregario. Se puede encontrar en bosques primarios y en zonas de alto disturbio antropogénico. Es un dise minador de semillas importante en largas dis
tancias y la forma en la que busca alimento en la hojarasca permite el ingreso y ciclado de nutrientes en suelo.
Información etnobiológica: Tiene varios orígenes, de acuerdo con cuantos acompa ñantes tenga el cerrillo (manada). El que va solo tiene un origen, el que va en pareja otro origen, el que va en manada de tres, cua tro o cinco tiene otro origen. El que va solo tiene su origen en el chorro de Araracuara. Hecho de balso, lo formó la Luna, como ensayando el pez serrucho que está en el chorro. Cuando él [la Luna] lo formó, el pez serrucho, para desquitarse del hermano (del pez serrucho), ensayando hizo dos, los lan zaron al agua, los devoraron [referencia a la historia del origen del baile de amoka]. Uno quedó como un borugo grande, y el otro quedó como cerrillo. El que anda de a dos, lo creó el abuelo trabajador de centro. Le habían hecho una invitación, él andaba cazando para llevar algo al baile, pero no cogía cacería. Llegó la madrugada y él no tenía nada, entonces, andando por el monte, él estiraba los pies. Se sentó en la puerta con la mujer diciendo que le sacara las espinas. Cuando él miró hacia el patio vio la planta de chontaduro marchitada. Él se preguntó qué había pasado con su chontaduro, cogió el hacha y empezó a tumbarla, cayó y des pedazó el palo, la palma, ahí estaba lleno de mojojoy pequeño. Él dijo: “esta va a ser mi cacería”, recogió el mojojoy y lo amarró patarasca, lo moquió y lo convirtió en dos cerrillos (Eduardo Paky).
Cerrillo. Fotografía de Emőke Dénes, disponible en <https:// commons.wikimedia.org/wiki/File:Em_-_Pecari_tajacu_-_1.jpg

129
PLANTAS

 Achiotes recibiendo luz. Fotografía de Tomás Hernando Rojas Tafur.
Achiotes recibiendo luz. Fotografía de Tomás Hernando Rojas Tafur.
TÚUGIY
AZAÍ, PALMITO
Euterpe precatoria (Mart., 1842)
Familia: Arecaeae Azaí. Ilustración de Diego Aguilera.
Información biológica: Palma nativa del norte de Suramérica, que crece en bosques húmedos de tierras bajas y zonas inunda bles. Tallo solitario o posiblemente cespi toso, erecto. Tiene aproximadamente de 15 a 20 m de altura y una corona de aproxima damente 20 hojas con 60 a 90 pinnas. La inflorescencia es un pedúnculo con raquis y raquilas péndulas igualmente. Los fru tos son drupas de aproximadamente 1 cm, de color violeta a negro. Se usa principal mente en las comunidades para la elabora ción de jugos por maceración y de caguana por medio del cocimiento de los frutos y la mezcla con los almidones de yuca.

132
CAIMO, CAIMITO, AGUAÍ
Pouteria caimito (Ruiz & Pav) (Radlk. 1882)
Familia: Sapotaceae

Caimo. Ilustración de Diego Aguilera.
Información biológica: Árbol nativo del norte suramericano de aproximadamente 6 a 8 m de altura. Crece en zonas bajas y húmedas, como la Amazonia. Hojas alter nas, más o menos ovadas. Flores solita rias o fascículos axilares. El fruto es una baya amarilla o pardo morado con 1 a 4 semillas, que se consume principalmente como fruta fresca o muy rara vez como jugo, por su acidez. Su madera de utiliza en la construcción.
M SÉSEVA
133
NÍM ’O
GUACÚRI
Poraqueiba sericea Tul., 1849)
Familia: Metteniusaceae

Guacuri. Ilustración de Diego Aguilera.
Información biológica: Árbol nativo de la Amazonia, que crece aproximadamente 30 a 60 m de altura. Crece en zonas bajas y húmedas. Sus son hojas opuestas, ova das y coriáceas. Tiene inflorescencia en panícula terminal o axilar. El fruto es una drupa generalmente verde amarilla, naranja o morada. Lo utilizan en las comunidades principalmente para hacer jugo o en la pre paración de Caguana.
134
MÓMO’O
CHONTADURO
Bactris gasipaes (Kunth, 1815)

Familia: Arecaceae
Chontaduro. Ilustración de Diego Aguilera.
Información biológica: Palma nativa de la zona tropical del continente americano. Crece en un solo tallo delgado con espinas aciculares desde la base. Crece entre 18 a 22 m de altura en zonas húmedas como la Amazonia. Tiene hojas pinnadas con un peciolo muy largo. El fruto es una drupa generalmente anaranjada o amarilla que casi siempre se consume como fruta fresca y en jugo. Es una planta que puede presen tar ciertas variaciones morfológicas dentro del grupo amazónico ya que ha sido con tundentemente domesticada desde hace muchos años.
135
JÁKU’O

MARACA, BACAO, MAJAMBO, PATAXE Theobroma bicolor (Humb. & Bonpl., 1806)

Familia: Malvaceae
Maraca. Ilustración de Diego Aguilera.
Información biológica: Árbol nativo de la zona tropical del continente americano. Crece generalmente con muchas ramifica ciones, y alcanza entre 8 a 15 m de altura en suelos con buen drenaje. Sus hojas son oblongas u ovadas y tiene múltiples inflo rescencias axilares. El fruto es una baya muy grande verde amarilla a amarilla plena con vetas cafés, con múltiples semillas uni das por un arilo blanquecino comestible. Se usa principalmente como fruta fresca y las semillas se tuestan para comer.
136
BÁAKU’O
UVA CAIMARONA O CAMU CAMU
Myrciaria dubia (Kunth) (McVaugh, 1963)

Familia: Myrtaceae
Uva caimarona. Ilustración de Diego Aguilera.
Información biológica: Árbol pequeño nativo de la Amazonia. Tiene un tallo leñoso verdusco o marrón con láminas de corcho desprendible. Posee hojas simples y opuestas generalmente elípticas. Crece aproximadamente de 3 a 5 m. Sus flores son solitarias y blancas, y la fruta es una baya globosa similar a una uva de color violeta o morado. Se usa principalmente en estas comunidades para comer como fruta fresca.
137
SI’O
GUAMA
Inga edulis (Mart., 1837)
Familia: Fabaceae
Información biológica: Árbol de porte mediano a grande que alcanza los 30 m de altura. Es nativo de las zonas tropicales de América. Tiene un tallo leñoso grisáceo o café más o menos liso, con lenticelas. Tiene hojas compuestas, alternas y pinnadas con un raquiz alado, y flores sésiles o pedicela das amarillo verdosas. El fruto es una vaina curvada grande con semillas grandes con arilo carnoso blanquecino. Se cultiva prin cipalmente por su alta capacidad de fijar nitrógeno al suelo, pero en estas comuni dades se usa principalmente para el con sumo como fruta fresca.

138 T
Guama. Ilustración de Diego Aguilera.
COCUY
Macoubea guianensis (Aubl., 1775)

Familia: Apocynaceae
Información biológica: Árbol nativo de las zonas tropicales de América, que está pre sente en tierras bajas no inundables hasta los 1600 m aproximadamente. Alcanza una altura de 20 a 22 m y presenta látex blanco. Tiene hojas simples, opuestas, generalmente elípticas. Inflorescencia en un corimbo terminal. El fruto es una baya subglobular a manera de corazón de color café o pardo. Posee varias semillas que flo tan de un líquido viscoso parecido a miel. Se consume la miel lo más pronto posible antes de que se oxide y la baya, que suele ser muy dura, se utiliza algunas veces como cuenco, taza o vaso para líquidos.
Cocuy. Ilustración de Diego Aguilera.
139 N
KUJE’E
‘AÑAJE’E
MARAÑÓN
Anacardium occidentale (L., 1753)

Familia: Anacardiaceae
Información biológica: Árbol nativo de las zonas tropicales de América. Alcanza los 8 m de altura. Presenta hojas simples, alternas, oblongas y coriáceas. Posee flo res pequeñas pentámeras agrupadas en panículas terminales. Su fruto es una nuez reniforme grisácea o amarillenta sostenida por un pedicelo engrosado rojizo general mente. Se usa principalmente en jugo o como fruta fresca para comer.
Marañón. Ilustración de Diego Aguilera.
140
KÚME’E
MILPESO
Oenocarpus bataua (Mart. 1823)
Familia: Arecaceae

Cocuy. Ilustración de Diego Aguilera.
Información biológica: Árbol nativo de las zonas tropicales de América, que está pre sente en tierras bajas no inundables hasta los 1600 m aproximadamente. Alcanza una altura de 20 a 22 m y presenta látex blanco. Tiene hojas simples, opuestas, generalmente elípticas. Inflorescencia en un corimbo terminal. El fruto es una baya subglobular a manera de corazón de color café o pardo. Posee varias semillas que flo tan de un líquido viscoso parecido a miel. Se consume la miel lo más pronto posible antes de que se oxide y la baya, que suele ser muy dura, se utiliza algunas veces como cuenco, taza o vaso para líquidos.
141
CHÉRE
MILPESILLO, MANOCO, PUNÁMA
Oenocarpus bacaba (Mart. 1823)

Familia: Arecaceae
Milpesillo. Ilustración de Diego aguilera.
Información biológica: Palma solita ria, nativa de la región biogeográfica de la Guayana y la Serranía de la Macarena entre 60 y 300msnm (departamentos del Amazonas, Caquetá, Guainía y Vaupés). Es un tronco solitario de hasta 25m de altura de color marrón a grisáceo, la vaina es de color verde oscuro a violeta. La corona
se conforma por 15 hojas erectas aproxi madamente con raquis de hasta 6m con pinnas rígidas de cada lado del raquis. Inflorescencia con pedúnculo de hasta 10cm y bráctea de 2m de longitud. Frutos de 2cm de diámetro de color morado negruzco al madurar, que se usan principalmente para comer frescos o preparar bebidas.
142
CANANGUCHO
Mauritia flexuosa (L., 1782)
Familia: Arecaceae
Información biológica: Se distribuye ampliamente en el norte y centro de Suramérica, preferiblemente en terre nos inundables de la Amazonía. Forma amplias asociaciones en las orillas de los ríos denominadas “morichales”. Es una palma solitaria con tronco de entre 20 y 35m de altura y 40cm de diámetro. La corana la conforman 11-14 hojas con raquis de 2.5m de longitud aproximada. La inflorescencia es erecta con pedúnculo de 1m y raquis de 1.5m. Los racimos pue den contener más de mil frutos de 7cm de largo por 6 cm de diámetro, con color rojo oscuro o Vinotinto. Su fruto es amargo, carnoso, anaranjado y la semilla color cas taño; se consume la pulpa de los frutos porque contiene proteínas, grasa, vitami nas y carbohidratos. Se come fresca direc tamente o se usa para fabricar bebidas y dulces. También se extrae aceite. Del tallo se pueden extraer palmitos comestibles y de las hojas fibras para fabricar cordeles, cestas y chinchorros, por ejemplo.

143
‘INÓ’O
Canangucho. Ilustración de Diego Aguilera.
KUYÁ’O
ANÓN
Rollinia mucosa (Jacq. 1764)
Familia: Annonaceae

Información biológica: Árbol nativo del occidente amazónico, que crece hasta 10m de altura. Posee ramas alargadas, algunas verticales. Ramifica casi desde la base. Las hojas pueden ser de 12 a 15 cm y las flores son hermafroditas solitarias o en pares, con tres sépalos y seis pétalos de color verde
claro. Pesa de 300-1300 g y su tamaño de 10-14cm de altura y 6-16cm de diámetro. El fruto es de cónico a globoso, la pulpa es blanca y jugosa de sabor dulce. Produce, además, bastantes semillas y se utiliza prin cipalmente para comer directamente.
Anón. Ilustración de Diego aguilera.
MÉJEGI’O
LAUREL COLOMBIANO Endlicheria sp (Nees, 1833)
Familia: Lauraceae
Información biológica: Árbol nativo de los Andes y de la Amazonía de Colombia. Se distribuye en el norte y centro de Suramérica. Puede crecer hasta los 20 m de altura. Tiene un tronco único redon deado con corcho que se desprende en escamas. Hojas simples, alternas, coriá ceas y agrupadas hacia el ápice de las ramas. Posee inflorescencia axilar en panícula y frutos en capsula. Se usa como especie maderable por la calidad de su madera, pero en estas comunidades se utiliza principalmente como fruta fresca para comer o hacer jugo.

145
Canangucho. Ilustración de Diego Aguilera.
S ’O
JUANSOCO
Couma macrocarpa (Barbosa, 1891)
Familia: Apocynaceae
Información biológica: Árbol nativo de Centroamérica y Suramérica de tamaño mediano a grande con látex. Posee hojas verticiladas elípticas y la inflorescencia en panícula con flores rosadas. Tiene frutos globosos de 3cm de diámetro, carnosos con una sola semilla. Tiene varios usos, entre los que se destaca el tratamiento de diarrea ingiriendo el látex chicludo. El látex se usa también para plásticos y goma. La fruta es lechosa, como chicle, con sabor dulce.

146
M
Juansoco. Ilustración de Diego aguilera.
MADROÑA
Información biológica: Árbol nativo de los bosques Colombia, Venezuela y Panamá; su distribución hoy es desde Costa Rica hasta Bolivia y Brasil. En Colombia se dis tribuye por toda la costa pacífica hasta la cuenca amazónica. Es mediano de hasta 15m de altura; de tronco recto, corteza con lenticelas dispuestas verticalmente, ramas opuestas o subverticiladas inser tadas en ángulo recto al tronco. Secreta latex. Posee hojas simples y opuestas que forman una copa piramidal, sin estípulas y entre elíticas y oblongas de color verde claro en el envés, y flores en fascículos
axilares con pedicelos largos y 2 sépa los redondeados en el ápice. Los frutos son bayas ovaladas a oblongas amarillas aromáticas, jugosas y de sabor agridulce. Contienen entre 1 y 3 semillas. El fruto se consume directamente, aunque con su pulpa también se elaboran jaleas y jugos. La infusión de la corteza se emplea para combatir la fiebre. También se usa como una especie ornamental por su porte y belleza, además de su resistencia a plagas y enfermedades y fácil adaptación a dife rentes condiciones.

147
MÁNI’O
Garcinia madruno (Kunth, 1989) Familia: Clusiaceae Madroña. Ilustración de Diego Aguilera.
DÉ’E USUTA DECU
AJÍ, CHICHI DE PERRO DE AHUMAR
Capsicum chinense (von Jacquin, 1776)
Familia: Solanaceae
Información biológica: Planta herbácea, ramificadas, de hojas pecioladas, solitarias o en pares, ovadas con ápice acuminado, con base cuneada escasamente pubescen tes. Posee flores en pares raramente soli tarias con pedicelo. El fruto es una baya oblonga a globosa amarilla a roja, que es utilizado como ingrediente en las comidas. Se prepara, por ejemplo, en salsas picantes de acompañamiento. También tiene algunas aplicaciones medicinales.

148
Ají. Ilustración de Diego aguilera.
BÁÑO’O
TABACO
Nicotiana tabacum (L., 1753)
Familia: Solanaceae
Tabaco. Ilustración de Diego Aguilera.
Información biológica: Planta herbácea perenne nativa de América tropical y de cuyas hojas se obtiene la mayor parte del tabaco que se consume en el mundo. Es robusta, de hasta 3m de altura; su tallo es erecto, circular, piloso y viscoso al tacto. Hojas densas y grandes de hasta 40cm de largo por 20cm de ancho, alter nas, de ovadas a lanceoladas color verde pálido. Tiene flores actinomorfas, herma froditas, bractadas y pediceladas, de color

verde amarillento o rosadas. Su fruto es un ovoide capsular de 2cm de largo.
El tabaco es de origen andino y su uso data de alrededor de 6000 años a. C. Es de importancia cosmogónica para comu nidades indígenas de estas regiones y en la actualidad tiene gran importancia eco nómica. Su alcaloide característico es la nicotina que se sintetiza en las raíces y se acumula en las hojas.
149
JÁN GAI
YUCA, MANDIOCA, CASAVA, GUACAMOTA
Manihot esculenta (Crantz, 1766)
Familia: Euphorbiaceae
Yuca. Ilustración de Diego aguilera. Información biológica: La yuca es un arbusto perenne muy diverso, capaz de alcanzar un tamaño entre 1 y 5 m de altura. Sus hojas son simples, presentan una lámina foliar palmeada con un número variable de lóbulos y un peciolo largo y delgado, de color variable, según la variedad rojo o rojo verdoso, verde rojizo y verde. Las flo res masculinas y femeninas se encuentran separadas, con una ramificación simpodal.
La yuca se puede dividir en dos grupos: brava o amarga y dulce, dependiendo del contenido de cianógenos que contengan sus raíces. Su uso principalmente es la prepa ración de diversidad de alimentos a partir de las raíces. En algunas regiones se consu men las hojas por su alto aporte nutricio nal. También se usa industrialmente en la elaboración de comida para animales, pro ducción de pegantes, biocombustibles, cer vezas, entre otros.

150


Banca: Barbasquear: Bejuco: Bocana: Bodoquera: Boyar: Brujería: Cabecera:
Asiento ritual que utiliza un pensador. También hace referencia al sitio de origen de cada una de las especies, por lo que se nombra según la especie en particular.
Atrapar los peces que suben a la superficie tras intoxicarlos con la liana macerada de barbasco.
Tallo largo, fuerte y delgado que se desprende de algunas plantas tropicales. Suele emplearse en la elaboración de tejidos de cestería.

Entre los féenem na’a, la bocana remite a una ubicación geográfica que señala el occidente o el lugar en el que desemboca el río.
Cerbatana utilizada para disparar dardos.
Volver a flotar tras haber estado en tierra. Conocimientos chamanísticos que, según el contexto, pueden ser usados con propósitos benéficos o maléficos.
Entre los féenem na’a, la cabecera remite a una ubicación geográfica que señala el oriente o el lugar en el que nace el río.
152
Caguana: Cananguchales: Casabe: Catarijano: Chagra:
Bebida refrescante, con textura similar a la de la colada, elaborada al mezclar y cocinar una porción de almidón de yuca con agua. Suele combinarse con la pulpa de alguna fruta.
Bosques especiales de pantano sobre suelos anegados, turbosos, valles aluviales y terrazas bajas en la región de la Amazonia, en donde generalmente abundan las palmas de canangucho Mauritia flexuosa.
Torta hecha a base de harina de yuca brava o de almidón, y tostada en un tiesto de barro, un budare o una plancha.
Canasto tejido de la hoja de la palma de milpeso y otras especies similares.
Huerto, plantación familiar dedicada a gran variedad de cultivos, como la yuca, el plátano, la piña, etc.
Endietado: Enfriaje:
Persona que guarda dieta.
Época particular del año ubicada a finales de julio y precedida en los meses previos por una serie de enfriajes falsos. El final del enfriaje propio da paso al inicio del calendario ecológico para los féenem na’a. La temperatura durante estos días se reduce considerablemente por el ingreso de una corriente de aire de los vientos alisios. El enfriaje también remite a una época mítica en que fue realizado un baile por el abuelo de enfriaje en el que bailaron los animales. Es conocido también como friaje.
153
Tronco de madera que se clava en la tierra para sostener el techo de una maloca.
Dar con garrote, pegar, golpear.
Especie vegetal (Couma guianensis) de la que se extrae un látex para obtener caucho.
Casa comunal en la que se realizan las celebraciones rituales. Polvo fino hecho a base de hoja de coca tostada y macerada, mezclada con ceniza de yarumo.
Lugar de la maloca donde se reúnen los hombres a conversar y a mambear.
Práctica que involucra el consumo oral de mambe, combinando el polvo hecho a base de la hoja de coca con la saliva y manteniéndolo dentro de la boca mientras se realizan otras actividades dentro o fuera del mambeadero.
Bebida dulce de gran importancia cultural, obtenida de la cocción del jugo de la yuca dulce o yuca de manicuera.
Instrumento utilizado para exprimir la masa de yuca brava rallada para preparar el casabe. Tiene una forma alargada y tubular. Ahumar.
Conjunto de material vegetal compuesto por palos y troncos de madera transportados por el río y agrupado en un lugar.
154
Mambeadero:
Estantillo: Garrotiar: Juansoco: Maloca: Mambe:
Mambear: Manicuera: Matafrío: Moquear: Palizada:
Pasera: Paserado: Patarasca: Popai: Rasquiñoso: Yarumo:
Lugar encima del fogón donde se ahuman pescados y carnes con el fin de preservarlos.
Una pasera llena.
Plato de comida envuelto y cocido en hoja de plátano.
Planta leñosa del género Eschweilera spp., utilizada antiguamente para iluminar un sitio en la noche. Que produce picazón.
Cecropia peltata (Urticaceae), árbol de rastrojo que crece en conjunto sobre zonas erosionadas. Las cenizas de su hoja quemada se mezclan con la hoja de coca macerada en la elaboración del mambe.
155
BIBLIOGRAFÍA
ARTRÓPODOS
Álvarez, D., Gómez, D., Martínez, J., Mendoza, H., & Ruiz, S. (2013). Uso de microhábitat por escorpiones en un relicto de bosque seco tropical del Caribe colombiano. Revista Colombiana de Entomología, 39(2), 301-304.
Amat-García. G., M. Andrade-C., G., & Amat-García, E. (Eds.). (2007). Libro Rojo de los Invertebrados Terrestres de Colombia. Conservación Internacional Colombia; Instituto de Ciencias Naturales-Universidad Nacional de Colombia.
Arias, D. Q., & Cupul-Magaña, F. G. (2013). First record of Scolopendra gigantea Linnaeus, 1758 (Chilopoda: Scolopendromorpha: Scolopendridae) from Panamá. Boletín del Museo de Entomología de la Universidad del Valle, 14(2), 12-15.
Cifuentes, Y., Estrada-Gomez, S., Vargas-Muñoz, L. J., & Perafán, C. (2016). Description and molecular characterization of a new species of tarantula, Pamphobeteus verdolaga, from Colombia (Araneae: Mygalomorphae: Theraphosidae). Zoologia, 33(6).
Cupul-Magaña, F. G. (2014). Los ciempiés escolopendromorfos (Chilopoda: Scolopendromorpha) de México: clave para géneros. Revista Colombiana de Entomología, 40(2), 286-291.
De la Fuente Coello, D. (2000). Los pompílidos: un exitoso ejemplo de predoparasitismo. Revista ibérica de aracnología, (1), 73-76.
Dias, S. C., & Machado, G. (2006). Microhabitat use by the whip spider Heterophrynus longicornis (Amblypygi, Phrynidae) in Central Amazon. The Journal of Arachnology, 34(3), 540-544.
Fernández, F. (1993). Hormigas de Colombia III: Los géneros Acanthoponera Mayr, Heteroponera Mayr y Paraponera Fr. Smith (Formicidae: Ponerinae: Ectatommini). Caldasia, 17(2), 249-257.
156
Fernández, F. (2000). Avispas cazadoras de arañas (Hymenoptera: Pompilidae) de la región Neotropical. Biota Colombiana, 1(1).
Fernández, F., Castro, V., Rodríguez, J., Waichert, C., & Pitts, J. P. (2017). Fauna de Colombia: Avispas cazadoras de arañas de Colombia:(HYMENOPTERA: POMPILIDAE). Universidad Nacional de Colombia.
Hazzi, N. A., & Hormiga, G. (2021). Morphological and molecular evidence support the taxonomic separation of the medically important Neotropical spiders Phoneutria depilata (Strand, 1909) and P. boliviensis (FO Pickard-Cambridge, 1897) (Araneae, Ctenidae). ZooKeys, 1022(1), 13-50.
Martínez-Quintero, B. G., Echeverri-Rubio, A., & GaviriaOrtiz, F. G. (2017). Distribución potencial de Oxysternon conspicillatum (WEBER, 1801) en Diferentes escenarios de cambio climático en Colombia. Boletín Científico. Centro de Museos. Museo de Historia Natural, 21(2), 190-206.
Martins, R., & Bertani, R. (2007). The non-Amazonian species of the Brazilian wandering spiders of the genus Phoneutria Perty, 1833 (Araneae: Ctenidae), with the description of a new species. Zootaxa, 1526(1), 1-36.



Peralta, L. (2013). Las arañas del banano (Phoneutria spp.), las más temidas de Centro y Sur América. Cartilla. https://bit.ly/2RiZu2x.
Pérez, R., Condit, R., & Lao, S. (1999). Distribución, mortalidad y asociación con plantas, de nidos de Paraponera clavata (Hymenoptera: Formicidae) en la isla de Barro Colorado, Panamá. Revista de biología tropical, 47(4), 697-709.
Pérez-Miles, F. (Ed.). (2020). New World Tarantulas. Taxonomy, Biogeography and Evolutionary Biology of Theraphosidae. Zoological Monographs. Springer.
Piek, T., Duval, A., Hue, B., Karst, H., Lapied, B., Mantel, P., Nakajima, T. Pelhate, M. & Schmidt, J. O. (1991). Poneratoxin, a novel peptide neurotoxin from the venom of the ant, Paraponera clavata Comparative Biochemistry and Physiology Part C: Comparative Pharmacology, 99(3), 487-495
157
Ramos-Patlán, F. D., Salas-Araiza, M. D., Guzmán-Mendoza, R., Pérez-Romero, L., Martínez-Jaime, O. A., & Núñez-Palenius, H. G. (2018). Notas sobre la presencia y distribución de especies de mantis en Guanajuato. Entomología Mexicana, 5, 118-124.
Rates, B., Bemquerer, M. P., Richardson, M., Borges, M. H., Morales, R. A., De Lima, M. E., & Pimenta, A. M. (2007). Venomic analyses of Scolopendra viridicornis nigra and Scolopendra angulata (Centipede, Scolopendromorpha): shedding light on venoms from a neglected group. Toxicon, 49(6), 810-826.
Reveillion, F., Wattier, R., Montuire, S., Carvalho, L. S., & Bollache, L. (2020). Cryptic diversity within three South American whip spider species (Arachnida, Amblypygi). Zoological research, 41(5), 595–598.
Rojas-Runjaic, F. J., & Becerra, A. C. (2008). Diversidad y distribución geográfica de la escorpiofauna del estado Zulia, Venezuela. Boletín del Centro de Investigaciones Biológicas, 42(4), 461-477.
Salazar Escobar, J. A. (2005). Algunos cicádidos de Colombia (Homoptera: Cicadidae). Boletín Científico, Centro de Museos, Museo de Historia Natural, 9, 192-204.
Toro Segovia, L. J., Téllez Ramírez, G. A., Henao, D. C., Rivera, J. D., Bedoya, J. P., & Castaño, J. C. (2017). Identification and characterization of novel cecropins from the Oxysternon conspicillatum neotropic dung beetle. PloS one, 12(11), e0187914.
Valenzuela-Rojas, J. C., González-Gómez, J. C., Van der Meijden, A., Cortés, J. N., Guevara, G., Franco, L. M., Pékar, S. & García, L. F. (2019). Prey and venom efficacy of male and female wandering spider, Phoneutria boliviensis (Araneae: Ctenidae). Toxins, 11(11), 622.
Vasco-Palacios, A. M., Suaza, S. C., Castanõ-Betancur, M., & Franco-Molano, A. E. (2008). Conocimiento etnoecológico de los hongos entre los indígenas Uitoto, Muinane y Andoke de la Amazonía Colombiana. Acta amazónica, 38(1), 17-30.
Wolff Echeverri, M. (2006). Insectos de Colombia. Guía Básica de familias. Universidad de Antioquia.
158
ANFIBIOS
Brown, J., Twomey, E., Amézquita, A., Caldwell, J., De Souza, M., Lötters, S., Von May, R., Melo-Sampaio, P., Mejia-Vargas, D., Pérez-Peña, P., Pepper, M., Poelman, E., Sanchez-Rodriguez, M., & Summers, K. (2011). A taxonomic revision of the Neotropical poison frog genus Ranitomeya (Amphibia: Dendrobatidae). Zootaxa 3083:1-120.
De la Riva, I., Köhler, J., Lötters, S., & Reichle, S. (2000). Ten years of research on Bolivian amphibians: updated checklist, distribution, taxonomic problems, literature and iconography. Revista Española de Herpetología, 14(1), 19-164.



Frost, D. R. (2010). Amphibian species of the world: an online reference. Versión 5.4 [Base de datos electrónica] http://research.amnh.org/ vz/herpetology/amphibia/. American Museum of Natural History.
Heyer, W. R. (2005). Variation and taxonomic clarification of the large species of the Leptodactylus pentadactylus species group (Amphibia: Leptodactylidae) from Middle America, Northern South America, and Amazonia. Arquivos de Zoologia 37(3), 269-348.
Padilla, S. (2005). Actividad reproductiva de dos comunidades de anuros en el Parque Nacional Yasuní (tesis de licenciatura). Pontificia Universidad Católica del Ecuador.
Peloso, P. L. V., Sturaro, M. J., Forlani, M. C., Gaucher, P., Motta, A. P., & Wheeler, W. C. (2014). Phylogeny, taxonomic revision, and character evolution of the genera Chiasmocleis and Syncope (Anura: Microhylidae) in Amazonia, with descriptions of three new species. Bulletin of the American Museum of Natural History 386, 1-112.



Rivero, J. A. (1961). Salienta of Venezuela. Bulletin of the Museum of Comparative Zoology, Harvard College, 126, 1-207.
Rodríguez, L. O. y Duellman, W. E. (1994). Guide to the frogs of the Iquitos Region, Amazonian Perú. Asociación de Ecología y Conservación; Amazon Center for Environmental Education and Research; Natural History Museum, The University of Kansas.
Roithmair, M.E. (1994). Male Territoriality and Female Mate Selection in the Dart-Poison Frog Epipedobates trivittatus (Dendrobatidae, Anura). Copeia, 1994(1), 107-115.
Ron, S. R., Merino-Viteri, A., & Ortiz, D. A. (2021). Anfibios del Ecuador. Versión 2021.0. Museo de Zoología, Pontificia Universidad Católica del Ecuador. https://bioweb.bio/faunaweb/amphibiaweb.
159
REPTILES
Ávila-Pires, T. C. S. (1995). Lizards of Brazilian Amazonia (Reptilia: Squamata). Zoologische Verhandelingen, 299(1), 1-706.
Carvajal-Campos, A., & Torres-Carvajal, O. (2010). Hemidactylus mabouia moreau de jonnès, 1818 and H. frenatus schlegel, 1836 in western Ecuador: new records reveal range extension. Herpetozoa, 23(1/2), 90-91.
O’Shea, M. (2007). Boas and pythons of the world. New Holland; Princeton University Press.
Páez, V. P., Morales-Betancourt M. A., C., Lasso, C. A., Castaño-Mora O. V., & Bock, B. C. (Eds.). (2012). V. Biología y conservación de las tortugas continentales de Colombia. Serie Editorial Recursos Hidrobiológicos y Pesqueros Continentales de Colombia. Instituto de Investigación de Recursos Biológicos Alexander von Humboldt (IAvH).
Torres-Carvajal, O., Pazmiño-Otamendi, G., Ayala-Varela, F., & Salazar-Valenzuela, D. (2021). Reptiles del Ecuador. Version 2021.1. Museo de Zoología, Pontificia Universidad Católica del Ecuador. https://bioweb.bio/faunaweb/reptiliaweb
Uetz, P. (Ed.). (s.f.). The Reptile Database. http:// reptile-database.reptarium.cz/






Vitt, L. J., Ávila-Pires, T. C. S., Zani, P. A., Sartorius, S. S., & Espósito, M. C. (20z03). Life above ground: Ecology of Anolis fuscoauratus in the Amazon rain forest, and comparisons with its nearest relatives. Canadian Journal of Zoology 81(1), 142-156.
Vitt, L. J., Zani, P. A., Caldwell, J. P., & Carrillo, E. (1995). Ecology of the lizard Kentropyx pelviceps (Sauria: Teiidae) in lowland rain forest of Ecuador. Canadian Journal of Zoology, 73(4), 691-703.
160
AVES



Álvarez, M., Córdoba, S., Escobar, F., Fagua, G., Gast, F., Mendoza, H., Ospina, M., Umaña, A.M. & Villarreal, H. (2006). Manual de métodos para el desarrollo de inventarios de biodiversidad. Instituto Alexander von Humboldt.
Ayerbe Quiñones, F. (2018). Colibríes de Colombia. Serie: Avifauna Colombiana. (2ª ed.). WCS.
Ayerbe Quiñones, F. (2019). Guía ilustrada de la avifauna colombiana. (2ª ed.). WCS.



Chaparro-Herrera, S., Echeverry-Galvis, M. Á.; Córdoba-Córdoba, & S., Sua-Becerra, A. (2013). Listado actualizado de las aves endémicas y casi endémicas de Colombia. Biota Colombiana, 14 (2), 235-272.
Hilty S. L., & Brown W.L. (2001). Guía de las aves de Colombia. American Bird Conservancy Princeton Polychrome Press.
MINISTERIO DE AMBIENTE Y DESARROLLO SOSTENIBLE. (2017). Resolución 1912, por la cual se establece el listado de las especies silvestres amenazadas de la diversidad biológica colombiana continental y marino costera que se encuentran en el territorio nacional, y se dictan otras disposiciones. https://medioambiente.uexternado.edu.co/wp-content/ uploads/sites/19/2017/11/Resolución-1912-de-2017.pdf
Naranjo, L. G., Amaya, J. D., Eusse-González D., & CifuentesSarmiento Y. (Eds.) (2012). Guía de las especies migratorias de la biodiversidad en Colombia. Volumen 1. AVES. Ministerio de Ambiente, Vivienda y Desarrollo Territorial; Dirección de Bosques, Biodiversidad y Servicios Ecosistémicos, WWF.
Ralph, C.J., Geupel, G.R., Pyle, P., Martin, T.E., DeSante, F., & Mila, B. (1996). Manual de métodos de campo para el monitoreo de aves terrestres. United States Department of Agriculture. Forest Service. Pacific Southwest Research Station.
Remsen, J. V., Jr., Areta, E.I., Bonaccorso, E. Claramunt, S. Jaramillo, A., Lane, D. F., Pacheco, J. F., Robbins, M. B., Stiles, F. G., & Zimmer, K. J. Versión 20 de diciembre. A classification of the bird species of South America. American Ornithological Society. http://www.museum.lsu.edu/~Remsen/SACCBaseline.htm
Román, O. R., Jiménez, A. D., Román, J., Román, I., Suárez, Á., Gutiérrez, G., Jiménez, J. S., Briseño, J. S., Valdivieso, N., González, A. D., Gutiérrez, H., Vargas, M., Calderón, M. L., Matta, N. E., & Montenegro O. L. (2019). Guías etnobiológicas de Colombia: Ara Kuara Ua. Fauna del resguardo indígena Andoke de Aduche, (1), 8-127.
161
MAMÍFEROS
Acosta, L. E., Garbino, G. S., Gasparini, G. M., & Parisi, R. (2020). Unraveling the nomenclatural puzzle of the collared and white-lipped peccaries (Mammalia, Cetartiodactyla, Tayassuidae). Zootaxa, 4851(1), 60-080
Altrichter, M., Sáenz, J. C., Carrillo, E., & Fuller, T. K. (2000). Dieta estacional del Tayassu pecari (Artiodactyla: Tayassuidae) en el Parque Nacional el Corcovado, Costa Rica. Revista de Biología Tropical, 48(2-3), 689-702.
Ayure, S. & González, M. J. F. (2014). Registro notable del Perro de Orejas Cortas Atelocynus microtis (Carnivora: Canidae) en el trapecio amazónico, Colombia. Notas Mastozoológicas, 1(1), 6
Bejarano-Bonilla, D A., Yate-Rivas, A., & Bernal-Bautista, M. H. (2007). Diversidad y distribución de la Fauna quiroptera en un transecto altitudinal en el departamento del Tolima, Colombia. Caldasia, 29(2), 297-308.
Bonilla, M. M., Rodríguez, J., & Murillo, R. (2013). Biología de la Lapa (Cuniculus paca Brisson): una perspectiva para la zoocría. Ces. Med, Vet. Zootec., 8(1), 129-142.
Costa, R., Silveira, M., & Sousa, R. (2020). Vertical stratification of phyllostomid bats assemblage (Chiroptera, Phyllostomidae) in a forest fragment in Brazilian Southwestern Amazon. Neotropical Biology and Conservation. 15(2), 107-120.
Duque, L. (2009). Estimación de abundancia del delfín de río, Inia geoffrensis humboltiana de la cuenca del Orinoco colombiano (confluencia de los ríos Orinoco, Meta y Bita): un análisis de la efectividad del método de marca. Recaptura (tesis de pregrado). Universidad Jorge Tadeo Lozano. https://expeditiorepositorio.utadeo.edu.co/bitstream/ handle/20.500.12010/1216/T848.pdf?sequence=1&isAllowed=y
Gasparin, G. M., Rodriguez, S.G., Soibelzon, H. L., Beilinson, E., Soibelzon, E., & Velloso, R. (2014). Tayassu pecari (Link, 1795) (Mammalia, Cetartiodactyla): comments on its South American fossil record, taxonomy and paleobiogeography. Historical Biology: A Journal of Paleobiology, 26(6), 785-800.
162
Geudin, T., Hucks, P., Di Blanco, Y. (2018). Myrmecophaga tridactyla (Pilosa: Myrmecophagidae). Mammalian Species, 50(956), 1-13.






Góngora, D. F. (2012). Patrones de actividad y dieta de los micos maiceros (Sapajus apella) en un bosque de galería en el departamento de Vichada Colombia (tesis de pregrado). Universidad de los Andes. https://repositorio.uniandes.edu.co/handle/1992/15060
Lima, R. A., Guimaräes, S. B., Branco, E., Giese, E. G., Muniz, J.A., Ricci, R. E., & Miglino, B. A. (2016). Anatomia e Histología do trato urinário do macaco-prego (Sapajus apella). Pesq. Vet. Bras, 36(3), 221-226.
Montenegro, O. (2005). Programa Nacional para la conservación del género Tapirus en Colombia. Ministerio de Ambiente Vivienda y Desarrollo Territorial.
Mosquera-Guerra, F., Trujillo, F., Aya-Cuero, C., Jiménez-Ortega, A. M., & Mantilla-Meluk, H. (2019). Nuevos registros de cámara trampa de Atelocynus microtis (Sclater 1882) (Canidae: Carnivora) en el Parque Nacional Natural Serranía del Chiribiquete, Amazonia Colombiana. Rev. Biodivers. Neurotrop., 9(1), 1-5.
Navarro, X., Murillo, R., & Rojano, C. (2019). Fisiología y hematología de osos hormigueros gigantes en cautiverio (Myrmecophaga tridactyla. Linnaeus, 1758), en Colombia. Revista Sistemas De Producción Agroecológicos, 10(1), 48-54.
Paschoaletto, K. M., Gonçalves, L., Tan, C. K. W., Lemos, F. G., Ortiz, C., Peres, C. A., Negrões, N., Pinassi, A., Rohe, F., Abrahams, M., ZapataRios, G., Teles, D., Oliveira, T., von Mühlen, E. M., Venticinque, E., […] & Sollmann, R. (2020). Wild dogs at stake: deforestation threatens the only Amazon endemic canid, the short eared dog (Atelocynus microtis). R. Soc. Open Sci., 7. doi: 0.1098/rsos.190717
163
Paya, P., Sánchez, J., Guzmán, C., Rodríguez, P., & Roncancio, N. (2019). Ampliación del área de distribución del Mono maicero Cachón (Sapajus acapella): nuevo registro en el Parque Nacional natural Las Hermosas-GVC, Tolima, Colombia. Neotropical Primates, 25(1), 57-58.
Perez-Cortez, S., Reyna-Hurtado. R. (2008). La dieta de los pecaríes (Pecari tajacu y Tayassu pecari) en la región de Calakmul, Campeche. México. Revista Mexicana de Mastozoología, 12(1), 17-42.
Portillo, H., & Elvir, F. (2016). Distribución potencial de la Jaüilla (Tayassu pecari) en Honduras. Revista Mexicana de Mastozoología. 6(1): 15-23.
Rossi, R, Bodmer, R., Barbanti, J. & Guilherme, R. (2010). Amazonian brown brokcket deer Mazama nemorivaga. Neotropical cervidology. En J. Duarte & S. González (Eds.). Neotropical Cervidologu, Biologu and Medicin of Latin American Deer, pp. 202-210
Sabogal, S. (2010). Filogenia y conservación genética del pecarí de collar Pecari tajacu en cuatro departamentos de Colombia (tesis de maestría). Universidad Nacional de Colombia. https://repositorio.unal.edu.co/bitstream/ handle/unal/7603/190276.2011.pdf?sequence=1&isAllowed=y
Soriano, J. P. (2000). Functional Structure of Bat Communities in Tropical Rainforests and Andean Cloud Forests. Ecotropicos, 13(1):1-20.
Suárez, A. F. & Ramírez-Chaves H. E. (Eds.). (2015) Los carnívoros terrestres y semiacuáticos continentales de Colombia. Guía de campo. Universidad Nacional de Colombia.
164
PLANTAS
Calderón, E., Galeano, G., & García, N. (Eds). (2005). Libro rojo de plantas de Colombia. Vol 2: Palmas, frailejones y zamias. Serie Libros rojos de especies amenazadas. Instituto Alexander von Humboldt; Instituto de Ciencias Naturales de la Universidad Nacional
Castro, S., Barrera J., Carrillo M., & Hernández M. (2015). Asaí (Euterpe precatoria): Cadena de valor en el sur de la región amazónica. Instituto Amazónico de Investigaciones CientíficasSinchi; Ministerio de Ambiente y Desarrollo Sostenible.
Galeano, G. & Bernal, R. (2021). Oenocarpus bacaba Mart. En Bernal, R., S.R. Gradstein y M. Celis (Eds.). 2015. Catálogo de plantas y líquenes de Colombia. Instituto de Ciencias Naturales. Universidad Nacional de Colombia. https://doi.org/10.15472/7avdhn
Galeano, G. (1991). Las palmas de la región de Araracuara (Amazonia Colombiana). Programa TorpenbosColombia; Universidad Nacional de Colombia.
Grandtner, M. M., & Chevrette, Julien. (2013). Dictionary of Trees. Volume 2: South America. Nomenclature, Taxonomy and Ecology. Elsevier Academic Press.
Hernández M., & Barrera, J. (Eds.) (2010). Camu camu. Instituto Amazónico de Investigaciones Científicas-Sinchi; Ministario de Ambiente, Vivienda y Desarrollo Terrotorial.
SINCHI, (s.f.). Abarco. Cartilla. https://bit.ly/3GW02ma
Suárez, A., Venegas, C. S., Cárdenas, C. A., Jiménez, A. D., Román, J. D., Rojas, T. H., Ariza, E. A., Vargas, I. C., González, A. D., Mora, R. E. & de Vengoechea, C. (s.f.). Guías Etnobiológicas de Colombia. Namé’u y el abuelo de la bocana, (2), 10-79.
BIBLIOGRAFÍA GENERAL
Vengoechea, Consuelo De. (2012). Catégorisation lexicale en Muinane: Amazonie Colombienne (tesis de doctorado). Universidad de Toulouse le Mirail - Toulouse II, toulouse, Francia. https:// tel.archives-ouvertes.fr/tel-00796760/document
165
J
guías etnobiológicas de colombia nº3 .
BEGEJ
M
NA’A
‘GENTE DE OTROS TIEMPOS’: RELATOS DE ANIMALES Y PLANTAS DEL PUEBLO FÉENEM NA’AMUINANE, DEL MEDIO CAQUETÁ

Fue terminado de diseñar en el cuerpo voluntario de tramado para pgp el mes de marzo del 2022, ante un panorama ambiental que exhige enormes retos y responsabilidades para las comunidades y los gobiernos venideros, ya que los dirigentes actuales dejarán instaladas pesadas huellas como las del fracking.
Las familias tipográficas usadas fueron:
Ancizar Sans Ancizar Serif DIN Pro



g uías etnobiológicas de colombia es una publicación periódica en alianza con el grupo estudiantil “MUI” de la Facultad de Ciencias de la Universidad Nacional de Colombia en la que se resalta la importancia del conocimiento cultural, biológico y lingüístico de los pueblos indígenas en diálogo con la academia.
En esta tercera edición profundizamos en las historias y consejos que rememoran un tiempo en el que el mundo era habitado por otra humanidad. Estas expresiones del pueblo féenemina’a sobre esta anterior humanidad (que devendrá en animalidad) asoman otra posibilidad de percibir a nuestros interlocutores no-humanos: reconociendo la capacidad de intención inherente en ellos y formulando desde ahí otra ecología posible.





































































 Avelino en la maloca de su hermano, Adriano. Fotografía de Christian Cárdenas.
Avelino en la maloca de su hermano, Adriano. Fotografía de Christian Cárdenas.




 Ciempiés. Fotografía tomada por Diego Aguilera.
Ciempiés. Fotografía tomada por Diego Aguilera.

Abrazo nupcial, amplexo de dos ranas. Fotografía de Diego Aguilera
Abrazo nupcial, amplexo de dos ranas. Fotografía de Diego Aguilera




































 Loro verde del Caquetá. Fotografía de Sofía Venegas.
Loro verde del Caquetá. Fotografía de Sofía Venegas.
























 Paloma. Fotografía de Heine Rafael Gutiérrez.
Paloma. Fotografía de Heine Rafael Gutiérrez.























 Danta. Ilustración de Fillippe Paki (Villa Azul).
Danta. Ilustración de Fillippe Paki (Villa Azul).





 Achiotes recibiendo luz. Fotografía de Tomás Hernando Rojas Tafur.
Achiotes recibiendo luz. Fotografía de Tomás Hernando Rojas Tafur.































